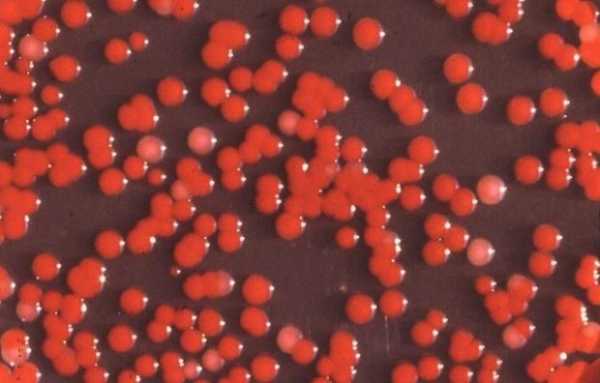

Отряд 731. Фабрика смерти — Никогда ни о чем не жалейте вдогонку…
В Японии есть музей «Отряд 731», печальная известность которого служит причиной массового паломничества сюда туристов со всего мира, но, прежде всего, самих японцев.Однако если посещение мемориала концлагеря Бухенвальд в Германии вызывает у немцев чувство содрогания, ненависти к нацизму и жалости к замученным, то японцы, особенно молодые, чаще всего выходят из музея с таким выражением лица, словно они посетили национальную святыню.
Еще бы, ведь, посещая музей, они узнают, что многие сотрудники отряда 731 после Второй мировой войны продолжали преспокойно жить и работать в их родной Стране восходящего солнца, и даже занимать ответственные посты. Включая тех, кто производил чудовищные биологические опыты на людях, которые по жестокости своей превосходили эсэсовского доктора Йозефа Менгеля.
Начало этой фабрике смерти было положено еще в 1926 году, когда трон Японии занял император Хирохито. Как известно он выбрал для эпохи своего правления девиз «Сёва» («Просвещенный мир»).
Но если большинство человечества отводит науке роль служения благим целям, то Хирохито, не скрывая, прямо говорил о ее предназначении: «Наука всегда была лучшим другом убийц. Наука может убить тысячи, десятки тысяч, сотни тысяч, миллионы людей за весьма короткий промежуток времени».
Император мог судить о таких страшных вещах со знанием дела: по образованию он был биологом. Он искренне полагал, что биологическое оружие поможет Японии завоевать мир, а ему, потомку богини Аматерасу, — исполнить свое божественное предназначение и править Вселенной.
Спустя четыре года после окончания Второй Мировой, в декабре 1949 года на трибунале Приморского военного округа, проходившего в городе Хабаровске, состоялся нашумевший судебный процесс по делу бывших японских военнослужащих, состоявших в секретных спецотрядах № 731, 100 и 1644. Солдатам японской армии были предъявлены обвинения в разработке и применении бактериологического оружия в годы войны. Кроме того, на трибунале было установлено, что жители городов советского Дальнего Востока — Владивостока, Уссурийска, Хабаровска, Благовещенска и Читы едва не стали жертвами этого оружия. Именно на эти города командование японской армии планировало сбросить авиабомбы, начиненные зараженными чумой блохами и другими смертоносными бактериями.
Лишь 12 человек были приговорены к разным срокам на Хабаровском суде 25-30 декабря 1949 г. Все подсудимые служили в «отряде 731», в котором занимались испытанием и производством бактериологического оружия и опытами на «брёвнах» — так в отряде называли пленных русских, китайцев, монголов. «Мы считали, что «брёвна» не люди, что они даже ниже скотов, — признавался один из экспериментаторов. — Среди работавших в отряде учёных и исследователей не было никого, кто хотя бы сколько-нибудь сочувствовал «брёвнам». И военнослужащие, и вольнонаёмные отряда считали, что истребление «брёвен» — дело совершенно естественное».
Японцы, как в своё время и нацистские «исследователи», ставили много опытов по переохлаждению человека: ноги и руки подопытных погружали в ледяную воду, а потом, голых и мокрых, их выводили на улицу. Чтобы определить, наступило ли обморожение, били палкой по рукам и ногам — если «брёвна» чувствовали боль, обморожение считалось неполным. Вернувшись в помещение, конечности жертв погружали в тёплую воду с разной температурой — так вырабатывался оптимальный режим лечения японских солдат. Иногда повреждения у несчастных подопытных оказывались настолько серьёзными, что мясо буквально слезало с рук и ног, обнажались кости. Но страдания «брёвен» на этом не заканчивались — с ампутированными конечностями, они продолжали движение по этому смертельному «конвейеру экспериментов». На них испытывали бактериальное и вирусное оружие, яды.
Чтобы изучить в деталях, как погибают танкисты, танки с запертыми в них людьми поджигали огнемётами. Чтобы наблюдать в реальном режиме, как изменяются органы при заражении разными инфекциями или под воздействием ядов, людей усыпляли и вскрывали живыми, все их органы изымали и распределяли между отделами — для научных целей. Однажды так «разобрали на детали» китайского ребёнка, которого просто украли, потому что для эксперимента понадобились детские органы.
В 20 км от Харбина в 1930-е гг. для отряда построили суперсекретное поселение. Там жили экспериментаторы, обслуга, были лаборатории и «склад брёвен» — тюрьма, где постоянно находилось до 300 человек. Всего за годы войны через отряд прошло более 3 тысяч, и ни один на свободу не вышел.
Почему же все эти злодеяния не рассматривались на Токийском суде, начавшемся в 1946 г.? «Многое ещё в этой истории остаётся неясным, так как не все архивы в России и США открыты, — рассказывает Виктория Романова, доктор исторических наук, профессор кафедры истории медицины, истории Отечества и культурологии Первого МГМУ им. И. М. Сеченова. — Мне удалось поработать в Архиве внешней политики РФ и изучить ранее не публиковавшиеся документы. Вот как представляются мне эти события.
К началу Международного военного трибунала для Дальнего Востока, проходившего в Токио, в распоряжении СССР и США были факты об использовании японцами во время войны бактериологических средств, но эта информация была скудной. В августе 1946 г. американцы там впервые озвучили обвинение о производстве японцами бактериологического оружия и испытании его на людях. Суд потребовал дополнительных доказательств. Американская сторона — а она играла главную роль на этом трибунале — сначала обратилась к советской за помощью в расследовании тех преступлений. В СССР, в лагерях японских военнопленных, были выявлены люди, служившие в «отряде 731» и причастные к разработке бактериологического оружия и опытам над людьми. Их решили направить на Токийский процесс в качестве свидетелей.
Однако вскоре США отказались от идеи сотрудничества с СССР, возможно, потому, что намеревались в одиночку получить секретную информацию по производству такого оружия. К тому времени они уже смогли обнаружить руководителя «отряда 731» Исии Сиро и его коллег. Им предложили судебный иммунитет в обмен на технологические секреты по производству бакоружия. Японцы сильно продвинулись в этом направлении, и есть мнение, что в США посчитали: повторение таких исследований потребует затрат гораздо больших, чем моральные потери из-за замалчивания тех преступлений.

Сиро Исии — командир отряда 731
В результате Исии Сиро не судили и не выдали СССР, на чём мы настаивали, а он был, по некоторым сведениям, переправлен в США, где занимался своей профессиональной деятельностью. Умер он в 1959 г. Москва решила организовать отдельный суд в СССР, проходивший в Хабаровске 25-30 декабря 1949 г. Ключевые фигуры и архивы оказались в руках США, под суд в Хабаровске попали сошки помельче, и это были единственные осуждённые японские военные, причастные к разработке и испытаниям на людях бакоружия. Китай как наиболее потерпевшая сторона — ведь «отряд 731» работал на оккупированной китайской территории в Маньчжурии — обвинений на Токийском процессе не выдвигал, так как функции защиты своих интересов передал США».
Многие участники «отряда 731» после войны сделали блестящую карьеру, став знаменитыми медиками, учёными. Бывали просто невероятные случаи. Гинекологи, заражавшие женщин венерическими болезнями, открыли знаменитый в Японии частный роддом. А «бойцы» отряда ежегодно встречались и вспоминали «минувшие дни».

Привязанные к столбу подопытные в ожидании взрыва бомбы с чумными блохами, 1940-е гг. Фото: Российский государственный архив кинофотодокументов
Некоторые медицинские эксперименты «отряда 731»:
* Людей заражали возбудителями чумы, холеры, тифа, дизентерии, сифилиса, прививали другие живые бактерии, заражали газовой гангреной.
* Расстреливали в опытных целях, изучая проникающие свойства пули и то, как поражаются разные органы.
* Выясняли, какое количество крови можно выкачать из человека, используя для этого специальные насосы.
* В вены вводили воздух, в лёгкие — дым и токсичные вещества, в желудок — токсичные вещества и гниющие ткани, в почки — мочу и кровь лошади; заменяли человеческую кровь кровью обезьян или лошадей — изучали, к каким последствиям всё это приводит.
*Подвешивали вниз головой или вращали в центрифуге с огромной скоростью, наблюдая, как человек умирает.
*Много часов облучали человека рентгеновскими лучами с целью исследовать их разрушающее действие на организм.
via
astori-18.livejournal.com
Самые страшные и чудовищные эксперименты над людьми в СССР и других странах

Человечество экспериментирует с тех самых пор, как праотцы взяли в руки острые камни и научились добывать огонь. Спустя века и тысячелетия накопленные знания множились и росли в геометрической прогрессии. ХХ век стал переломным во всех сферах науки, что в свою очередь стало толчком для многих учёных задаться вопросом «а что если?
». Чаще всего любопытство давало ощутимый результат, который мог помочь развитию рода людского. Однако некоторые представители учёного сообщества проводили эксперименты над людьми и другими живыми существами, которые входили далеко за рамки гуманности. Перед вами — десятка самых безумных из них.Русский учёный пытался создать гибрид человека и шимпанзе

Шимпанзе — один из ближайших родственников человека
В начале ХХ века русский учёный-биолог Илья Иванович Иванов стал одержим гениальной по его мнению идеей: скрестить человека и шимпанзе, создав жизнестойкое потомство. На первом этапе он вводил 13 самкам примата человеческую сперму. К счастью для окружающего мира, ни одна самка не забеременела (что огорчало Иванова). Однако Илья Иванович решил подойти к вопросу с другой стороны: он взял сперму обезьяны и хотел ввести её в женскую яйцеклетку.
Согласно теории Иванова, необходимо было как минимум пять женщин с оплодотворёнными яйцеклетками, чтобы эксперимент удался. Окружающие не разделяли энтузиазма исследователя, и Иванову всё сложнее было находить источники финансирования. Неожиданно «гения» отправили ветеринаром в небольшой уезд, где он умер спустя несколько лет, без денег и славы. Ходили слухи, что ему удалось договориться с одной женщиной о введении спермы шимпанзе в яйцеклетку, но результат, судя по всему, был отрицательным.
Павлов был настоящим злодеем, несмотря на заслуги перед наукой

Павлов ставил эксперименты над лучшими друзьями человека
Академик Павлов известен множеству людей благодаря собакам и колокольчикам (да, такие опыты были, и домашние любимцы усердно звонили каждый раз, когда хотели получить лакомство) — в 20-е годы ХХ века подобные наблюдения считались чуть ли не прорывом в психологии. Однако правда была далека от идеального понимания эксперимента: многие люди, жившие в то время, утверждали, что Ивану Петровичу Павлову была безразлична психология и его основным предметом исследования была пищеварительная система. Электрический ток, психотропные препараты и операции были нужны ему лишь для эмпирического наблюдения за физиологическими процессами. Преподавательская деятельность также мало волновала Павлова. Можно сказать, что он был одержим своим увлечением.
Эксперименты Павлова можно назвать жёсткими и негуманными, но именно они принесли академику Нобелевскую премию по физиологии в начале ХХ века. В рамках опытов он проводил «ложное кормление»: в горле собаки создавалось отверстие, или «фистула», через которое еда удалялась из пищевода: сколько бы животное ни съело еды, голод все равно не утихнет (еда не попадает в желудок). Павлов делал эти отверстия по всему пищеводу, чтобы узнать, как работает пищеварительная система собаки. Не удивительно, что у подопытных постоянно выделялась слюна. Коллеги Ивана Петровича закрывали глаза на такие негуманные способы проведения экспериментов, но забывать о жестокости учёного не стоит.
Учёные проверяли, думает ли голова после отсечения

Конструкция гильотины
Гильотина на заре своего существования была наиболее гуманным способом казни, если можно так выразиться. С её помощью можно было быстро и наверняка лишить человека жизни. Даже по сравнению с современными методами вроде электрического стула или смертельной инъекции гильотина выглядит обнадеживающе (хотя сложно говорить о таких вещах с позиции человека, для которого они не предназначены). Однако для французов во времена Революции была невыносима мысль, что голова, отделённая от тела, ещё какое-то время испытывает страдания и в ней протекают процессы жизнедеятельности. Впервые об этом заговорили после того, как у отрубленной головы появился румянец. Сейчас это бы легко объяснили с помощью физиологии, но несколько веков назад это событие заставило гуманистов думать над ним.
Исследователи проводили тесты на расширение зрачка и другие реакции головы сразу же после казни. Никто из учёных не мог сказать с точностью: является ли моргание или сокращение мышц рефлекторной реакцией или же осознанной. К слову, даже сейчас предоставить такую информацию невозможно, так как нет возможности провести эксперимент (для него потребуется обезглавить не один десяток человек). Однако люди науки уверены, что мозг сможет жить отдельно от тела не более нескольких сотых секунды.
Японский Блок 731 был создан для вивисекции и экспериментов по скрещиванию

Блок 731 с воздуха
Если вы услышите об ужасах Второй мировой войны, то, скорее всего, это будут разговоры о Холокосте или концлагерях фашистской Германии. Возможно, вы также услышите о зверствах со стороны солдат СССР или США, но крайне редко в разговорах всплывает Япония. И это несмотря на то, что страна была противником Союзников, причём весьма серьёзным. В первую очередь, японские военные захватывали в плен китайских граждан и десятками тысяч сгоняли их в лагеря для принудительного труда. Над китайцами издевались и ставили различные эксперименты.
Во время оккупации Китая было создано учреждение под названием «Блок 731». В стенах его учёные проводили бесчисленное количество опытов над пленными. В первую очередь это касалось вивисекции, то есть препарирования живого человека с целью изучения работы внутренних органов. Десятки тысяч человек пострадали от жестокости местных потрошителей. Самое страшное было то, что анестезия при этом не использовалась.
Йозеф Менгеле пытался сделать сиамских близнецов из обычных

Фото Менгеле во время его деятельности в Германии
Менгеле был известным в нацистской Германии врачом, который был одержим идеей превосходства арийской нации. Он совершил огромное количество преступлений против гуманности во время своих чудовищных экспериментов над пленными. Особую страсть он питал к близнецам, она была просто всепоглощающей. Некоторые люди верят, что опыты продолжаются до сих пор.
На территории Бразилии есть деревня, где количество близнецов просто зашкаливает. Учёные-генетики узнали, что у большинства женщин в поселении был один общий ген, который повышал шанс рождения близнецов. Причём он начал появляться после войны, когда немецкие эмигранты прибыли в эту местность. Это заставило многих людей предположить, что за аномалией стоит Менгеле. Однако никаких доказанных фактов сторонники теории не предоставили.
Однако не это самое страшное. Менгеле пытался сделать из двух самодостаточных близнецов единый организм. Проблемы со здоровьем начинались на первой стадии срастания кровеносной системы. Ни один из подопытных Йозефа не прожил дольше пары недель.
Отец фанат «Звёздного Пути», который пытался сделать своего сына билингвальным
Несколько лет назад вся Америка смеялась над горе-отцом, который хотел научить своего сына говорить по-клингонски. В его планах было создать такие условия, при которых сын общался бы с матерью, друзьями и социумом на английском языке, а с отцом — на вымышленном языке из вселенной «Стар Трек». Эксперимент провалился.
Отец отказался от опыта ещё до того, как его ребёнок пошёл в школу. Он заявил, что сын прекрасно разбирается в клингонском и может сообщить на нём обо всёх окружающих событиях. Эксперимент завершился из-за того, что у отца возник страх нарушения законодательства США. Сейчас сын практически не помнит выдуманный язык.
Доктор выпил раствор с бактериями, чтобы доказать свою правоту

Маршалл во время вручения Нобелевской премии
Врач и Нобелевский лауреат Барри Маршалл в середине 80-х годов ХХ века столкнулся с проблемой во время своих исследований: коллеги не поддерживали его теорию о том, что язву желудка вызывает не стресс, а особый вид бактерий. Все эксперименты на грызунах провалились, и Барри решил прибегнуть к последнему средству — проверить теорию на себе, так как найти подопытных было невозможно по этическим соображениям. Доктор Маршалл выпил бутыль вещества, содержащего Helicobacter Pyolori.
Вскоре учёный начал испытывать симптомы, которые были ему необходимы для подтверждения теории. Вскоре он получил заветную Нобелевскую премию. Стоит обратить внимание на то, что Барри Маршалл осознанно пошёл на мучения, чтобы доказать окружающим свою правоту.
Эксперименты над маленьким Альбертом

Малыш Альберт и безымянный психиатр
Серия экспериментов, проводимых над малышом по имени Альберт, выходила далеко за пределы норм морали и этики. Врач, подопытным которого был маленький ребёнок, решил проверить на человеческом существе эксперименты академика Павлова. Одна область его исследований лежала в области страхов и фобий: он хотел узнать, как работает страх и можно ли использовать его как стимул для обучения.
Врач, имя которого не оглашается, позволял Альберту играть с различными игрушками, а затем начинал громко кричать, топать и отбирать их у малыша. Через какое-то время ребёнок стал бояться даже приближаться к любимым предметам. Говорят, что Альберт боялся собак всю свою жизнь (одна из игрушек была плюшевым псом). Психиатр неоднократно проводил свои опыты над младенцами, чтобы доказать, что он просто может это делать.
Соединённые Штаты распылили бактерии Serratia Marcescens над несколькими крупными городами
Serratia Marcescens под микроскопом
Правительство Соединённых Штатов Америки обвиняется во множестве бесчеловечных экспериментов. Сторонники конспирологии уверены, что большая часть загадочных болезней, терактов и других событий с большим количеством жертв — результат деятельности государственных структур. Разумеется, большинство таких деяний скрыто под грифом «Секретно». Некоторые из теорий имеют доказательства. Так, в середине ХХ века правительство США исследовало влияние бактерии Serratia Marcescens на организмы людей, причём своих граждан. Власти желали посмотреть, насколько быстро может распространиться бактериологическое оружие во время атаки. Первым городом-полигоном стал Сан-Франциско. Эксперимент прошёл удачно, но начали появляться свидетельства смертельных исходов, после чего программу закрыли.
Ошибкой правительства была уверенность, что бактерия безопасна для человека, но в больницы поступало всё больше заболевших. Власти молчали до 70-х годов, когда президент Никсон наложил запрет на любые полевые испытания бактериологического оружия. Хоть представители Пентагона и уверяли, что считали бактерию безопасной, сам факт экспериментов над людьми является чудовищным примером действий лиц, имеющих власть. Такому поведению нет никаких оправданий.
Психологический эксперимент Facebook

Facebook: серый кардинал современности
За 5 прошедших лет люди забыли об эксперименте социальной сети Facebook, прошедшим в 2012 году. Во время этого опыта создатели FB демонстрировали одной группе пользователей только плохие новости, а другой — только хорошие. Подопытными стали сотни тысяч человек. Сотрудники компании хотели посмотреть, могут ли они управлять восприятием людей через посты в новостной ленте. Манипуляция Большого Брата оказалась столь удачной, что даже сами создатели испугались власти, которая попала им в руки.
Когда эксперимент получил огласку, разгорелся настоящий скандал. Руководство Facebook принесло извинение всем пострадавшим и пообещало впредь контролировать процесс выбора новостей, дабы подобного не произошло. Несмотря на скандал и снижения уровня доверия к социальной сети, она все ещё является самой популярной в мире. Хочется верить, что урок пошёл детищу Цукерберга на пользу, ведь оно обладает колоссальным объёмом личной информации, с помощью которой легко можно сломать чью-то жизнь или заставить человека сделать желаемое.
Человечество неумолимо двигается в будущее, которое в середине ХХ века рисовали писатели-фантасты. Прекрасный новый мир постепенно строится, но его приход ознаменован и новыми экспериментами, такими как пересадка головы, которая должна пройти уже декабре 2017 года. Какие ещё опыты, уходящие далеко за пределы понимания добра и зла, будут проведены? Да и страшно представить, о каких экспериментах правительства стран мира умалчивает. Быть может, в ближайшее время мы узнаем о таких деяниях, по сравнению с которыми факты из этого списка окажется детскими шалостями? Время покажет.
Понравился наш сайт? Присоединяйтесь или подпишитесь (на почту будут приходить уведомления о новых темах) на наш канал в МирТесен!
klikabol.mirtesen.ru
Кухня дьявола № 731: опыты над живыми людьми
Наш корреспондент побывал на территории некогда секретного объекта, где в годы войны японцы ставили опыты над пленными, среди которых были русские
Об этом чудовищном факте из истории Второй мировой войны, наверное, каждый что-то где-то слышал. Эта страница истории объемна, объемна эмоционально. Жестокость одних, безропотность других — но ведь и мужество людей, обреченных на мученическую смерть. Жирную точку в существовании японского «отряда 731», где массово велись опыты на живых людях, в августе 1945 года поставила Красная армия. Вскоре эта точка превратилась в многоточие: американское правительство укрыло от законного возмездия главных палачей в белых халатах, обеспечив им безбедную и долгую жизнь. В тех стенах, где были замучены тысячи людей, побывал корреспондент нашей газеты.
ВНИМАНИЕ! МАТЕРИАЛ НЕ РЕКОМЕНДУЕТСЯ ЧИТАТЬ ДЕТЯМ, А ТАКЖЕ ЛЮДЯМ СО СЛАБОЙ ПСИХИКОЙ.
Подготовка к беседе, которая так и не состоялась
Харбин сегодня — современный город с многомиллионным населением. Небоскребы, проспекты с нескончаемым потоком автомобилей, толкотня. После того как мы, группа иркутян, осмотрели все обязательные для посещения туристов достопримечательности столицы провинции Хэйлунцзян, сопровождавшие нас китайцы направили экскурсионный автобус на территорию печально известного «маньчжурского отряда 731».
Вечером после той экскурсии мы с Анатолием Каталеевым задумали, вернувшись в Иркутск, устроить на страницах нашей газеты беседу о том, существует ли в военное время какая-то особая мораль. О том, можно ли оправдать опыты над человеком, прикрываясь перспективой вероятных научных открытий.
Анатолий Каталеев имел право рассуждать на эти темы. Он — военврач, подполковник в отставке, работал начальником медицинской службы Восточно-Сибирского института МВД. После командировки в Нагорный Карабах за спасение жизни одного из курсантов Иркутского пожарного училища был удостоен государственной награды. В личных беседах в экспедиции по Монголии и Северному Китаю мы называли его просто доктор.
Готовясь к интервью с доктором, чтобы войти в тему, я решил прочитать документальную книгу известного японского писателя Сэйити Моримуры <Кухня дьявола>, в которой автор собрал уникальные материалы. По рассказам найденных им очевидцев, а также на основе секретных документов, полученных различными путями, он подробно и с хронологической точностью восстановил жуткие события конца 30-х годов и первой половины 40-х годов прошлого столетия, когда еще в 20 километрах от Харбина существовал секретный город, где, как шептались крестьяне из окрестных деревень, пропадают люди.
Книга про изуверов с учеными степенями
Честно говоря, у меня было несколько попыток осилить эту книгу. Но каждый раз я останавливался, когда ощущал, что мое состояние становится близким к шоку. К очередной попытке чтения я возвращался недели через две-три.
В первый раз смог дочитать только до той главы, где изуверы (кстати, некоторые с учеными медицинскими степенями) на операционном столе разделывали, по сути разбирая на отдельные органы (в прямом смысле слова!), живого мальчика.
Во вторую попытку я дошел до того места, где русский заключенный сумел напасть на охранника, открыть камеры с другими пленниками и захватить один из корпусов. Японцы не ожидали, что «подопытный материал» сможет сотворить такое.
Увы, но пути на свободу не существовало. Более часа широкоплечий шатен, имя которого неизвестно, отважно стоял под стволами десятков винтовок и говорил. Вооруженные до зубов японцы были смущены, они боялись подойти к нему. С русского языка им перевели: «Лучше сразу убейте. Это лучше, чем быть морскими свинками для ваших опытов». Того человека застрелили в упор, а всех обитателей взбунтовавшегося блока отравили ядовитым газом.
Когда я в очередной раз взял в руки книгу Моримуры, пришло страшное известие. Анатолия Каталеева, нашего доктора, с которым мы и задумывали этот материал, не стало. Его жестоко убили в лесу на трассе Иркутск — Ангарск.
Так что с помощью Сэйити Моримуры и в память о докторе…
База по водоснабжению — секретное подразделение
Наверное, мне повезло, что, попав на территорию «отряда 731», я особо о нем ничего не знал. Имелась, конечно, кое-какая информация о том, что это секретное подразделение Квантунской армии, официально замаскированное под Главную базу Управления по водоснабжению и профилактике частей Квантунской армии. О том, что здесь активно и успешно создавалось бактериологическое оружие для ведения невидимой войны против Советского Союза, причем прицел был именно на Сибирь. О том, что эти дьявольские методы испытывали на живых людях — военнопленных китайской Красной армии, борцах с японской оккупацией, наших красноармейцах и просто похищенных в окрестностях местных крестьянах. О жестоком времени Второй мировой много сказано…
Уже вернувшись в Иркутск и познакомившись с историческими свидетельствами, я понял то самое страшное, что не договаривала экскурсовод-китаянка, водя нас по мрачным до сегодняшнего времени коридорам спецкорпусов. Одни — рядовые сотрудники «отряда 731», — умерщвляя «подопытный материал», даже не задумывались, что это тоже люди. Другие, те, чье ближайшее будущее было единственным — смертью в мучениях, сумели сохранить мужество и веру в свои идеалы.
На складе бревен
Два кирпичных корпуса, соединенных переходом в виде буквы Н. За ними торчащие из земли массивные фундаменты — все, что осталось от двух секретных и особо охраняемых корпусов № 7 и № 8. Доступ сюда разрешался только ограниченному кругу сотрудников лабораторий. Здесь был «склад бревен». На небольшом удалении из-за деревьев видны бетонные трубы и часть стены — руины одного из корпусов по производству смертоносных бактерий. Пожалуй, это все, что сегодня осталось от зловещего и крупнейшего в мире научно-исследовательского центра по созданию бактериологического оружия.
А вокруг — небольшой, но утопающий в зелени парк и веселенькие розоватые многоэтажки. Харбин разросся, жилыми домами застроили и земли бывшего «отряда 731». А зачем месту пропадать?
Летом 1938 года эта территория, имевшая форму квадрата со стороной около шести километров, была объявлена особой военной зоной Квантунской армии. Всего за год посреди степи было построено громадное военное сооружение, окруженное рвом и забором с колючей проволокой, по которой был пропущен ток высокого напряжения. Внутри — многочисленные лаборатории, жилые дома примерно на три тысячи сотрудников, учебный центр, конный тренировочный манеж, большой лекционный зал, стадион и даже синтоистский храм. А кроме этого аэродром, электростанция, железнодорожная ветка. И тюрьма на сто человек.
Все, что творилось за забором, было скрыто за непроницаемой завесой высшей военной секретности. В «отряде 731» имелась даже своя истребительная авиация. Ей предписывалось сбивать любой летательный аппарат, даже принадлежащий своей армии, который без разрешения пролетел бы над территорией отряда.
Рецепты для смертельного врага
Как пишет Моримура, со времен Русско-японской войны японская армия считала Россию своим заклятым врагом. Одолеть СССР — в этом она традиционно видела свое предназначение. Именно поэтому «защитница северных рубежей» — Квантунская армия — все свои планы строила, рассматривая СССР как потенциального противника.
Но как небольшому островному государству одолеть столь мощного соседа? Стратегия боевых действий, охватывавших Маньчжурию, Корею и Южный Сахалин, была разработана в так называемом плане «Кантокуэн» («Особые маневры Квантунской армии») 1941 года. Особая ставка делалась на новое оружие — бактерии, невидимую смерть, способную накрыть огромные территории и одновременно поразить тысячи людей.
Главным идеологом и создателем бактериологического оружия стал начальник «отряда 731» генерал Сиро Исии, связавший в дьявольский узел науку и войну и придумавший использовать для экспериментов живых людей.
«Ноу фото!»
Уже потом, разглядывая схему Главной базы Управления по водоснабжению и профилактике частей Квантунской армии, я определил, внутри какого корпуса мы гуляли.
Корпус № 1. Два этажа, через каждый идет длинный коридор, по обе стороны которого комнаты разной величины. На беглый взгляд, присутствуют все признаки обычного музея — большое количество фотостендов, стеклянные шкафы с какими-то колбами, противогаз. В углу — керамическая авиабомба в разрезе, изобретенная генералом Исии для доставки смертоносных бактерий в места скопления врага. Кругом непонятные иероглифы и что-то бубнящая себе под нос экскурсовод.
И только большие витрины, внутри которых в объеме и масштабе воссозданы жуткие картины опытов над людьми, и молниеносная реакция сотрудников на мою фотовспышку («Ноу фото!») говорили о том, что это за музей.
Просторное помещение, где мне не позволили фотографировать, судя по схеме, было так называемой выставочной комнатой. Тысячи ее экспонатов в 1945 году в дни эвакуации отряда были уничтожены первыми. Большие банки с препаратами просто сбрасывали в реку. Интересно, к какому берегу они потом пристали?
Однако Моримуре по рассказам сотрудников хозяйственного управления удалось восстановить экспозицию той дикой «выставки».
Выставочная комната — изощренная пытка
«Итак, «выставочная комната», хотя и называлась комнатой, по размерам равнялась площади трех отделов хозяйственного управления: общего, финансового и отдела кадров. Тому, кто, пройдя по коридору от хозяйственного управления, достигал «выставочной комнаты» и открывал в нее дверь, прежде всего ударял в нос резкий запах формалина, затем внезапное нервное потрясение заставляло человека зажмурить глаза.
«Тот, кто впервые входил в эту комнату, впадал в шоковое состояние, и даже видавшие виды люди, шатаясь, искали опоры», — вспоминает бывший служащий отряда.
На полках, расположенных в два или три ряда вдоль стен, стояли наполненные формалином стеклянные сосуды диаметром 45 и высотой 60 сантиметров. В формалиновом растворе находились человеческие головы. Отделенные от шеи, с открытыми или закрытыми глазами, с колышащимися волосами, они тихо покачивались в стеклянном сосуде.
Головы с раздробленными, как гранатовый плод, лицами.
Головы, разрубленные на две части от темени до уха.
Головы распиленные, с обнажившимся мозгом.
Головы с разложившимися лицами, на которых невозможно распознать ни глаз, ни носа, ни рта.
Головы с широко открытыми ртами, с красными, синими, черными пятнами на коже.
Китайцы, монголы, русские…
Головы людей разных рас, мужчин и женщин, старых и молодых смотрели из коричневатого формалинового раствора на вошедшего в комнату и обращались к нему с немым вопросом: почему мы здесь?
В «выставочной комнате» были не только головы. Человеческие ноги, отрезанные по бедро, туловища без головы и конечностей, желудки и кишки, причудливо переплетенные в растворе, матки, некоторые с плодом. Короче говоря, это была выставка всех составных частей человеческого тела.
Бывший служащий отряда говорит: «Руководство отряда утверждало, что это были препараты трупов, подобранных на поле сражения у Халхин-Гола, но этому никто не верил, потому что в результате вскрытий живых «бревен» появлялись все новые и новые экспонаты».
Были среди них и совершенно невероятные. Например, человеческая рука, отрезанная по локоть. Владельцем этой руки был служащий отряда. Раз в месяц он приходил в «выставочную комнату», останавливался перед своей рукой и долго глядел на нее».
«Материал» достоин только смерти
Были ли специалисты и работники «отряда 731» нормальными людьми? Это с трудом поддается осознанию, но — да, проводя чудовищные эксперименты над себе подобными, они были нормальными. Многие приехали в «отряд» с семьями — работать и заниматься исследованиями. Немало среди них было и тех, кто, получая за свою работу хорошую зарплату, отправлял деньги в Японию — на обучение младших братьев и сестер или на лечение родителей.
Бывший служащий отряда говорил: «Мы не сомневались, что ведем эту войну для того, чтобы бедная Япония стала богатой, чтобы способствовать миру в Азии… Мы считали, что «бревна» — не люди, что они даже ниже скотов. Среди работавших в отряде ученых и исследователей не было никого, кто хотя бы сколько-нибудь сочувствовал «бревнам». Все — и военнослужащие, и вольнонаемные отряда — считали, что истребление «бревен» — дело совершенно естественное».
Им постоянно внушали, что «подопытный материал» или, как здесь говорили, «бревна», достойны только смерти. И у сотрудников отряда не возникало даже тени сомнения в этом. Но, судя по некоторым интервью с бывшими служащими отряда, которые провел Моримура, прозрение у них все же наступило — правда, через десятилетия. И отчаяние.
«Бревна» — это пленные, находившиеся в «отряде 731». Среди них были русские, китайцы, монголы, корейцы, схваченные жандармерией или спецслужбами Квантунской армии.
Жандармерия и спецслужбы захватывали советских граждан, оказавшихся на китайской территории, командиров и бойцов китайской Красной армии, попавших в плен в ходе боев, а также арестовывали участников антияпонского движения: китайских журналистов, ученых, рабочих, учащихся и членов их семей. Все эти пленные подлежали отправке в специальную тюрьму «отряда 731».
«Бревнам» не нужны были человеческие имена. Всем пленным отряда давали трехзначные номера, в соответствии с которыми их распределяли по оперативным исследовательским группам в качестве материала для опытов.
В группах не интересовались ни прошлым этих людей, ни даже их возрастом.
В жандармерии, до отправки в отряд, каким бы жестоким допросам их ни подвергали, они все же были людьми, у которых был язык и которые должны были говорить. Но с того времени, как эти люди попадали в отряд, они становились всего лишь подопытным материалом — «бревнами», и никто из них уже не мог выбраться оттуда живым.
«Бревнами» были и женщины — русские, китаянки, — схваченные по подозрению в антияпонских настроениях. Женщины использовались главным образом для исследования венерических заболеваний.
В центре блока «ро» находилось двухэтажное бетонное сооружение. Внутри оно было опоясано коридорами, куда выходили двери камер. В каждой двери имелось смотровое окошко. Это сооружение, сообщающееся с помещениями оперативных исследовательских групп, было «складом бревен», то есть специальной тюрьмой отряда.
По показаниям подсудимого Кавасимы на Хабаровском судебном процессе в 1949 году, в отряде постоянно находилось от 200 до 300 «бревен», хотя точно эти цифры неизвестны.
«Бревна», в зависимости от целей исследований, помещались в отдельные камеры или общие. В общих камерах содержалось от 3 до 10 человек.
По прибытии в отряд всякие пытки и жестокое обращение, которому подвергались пленные в жандармерии, прекращались. «Бревен» не допрашивали, не заставляли выполнять тяжелую работу. Более того, их хорошо кормили: они получали полноценное трехразовое питание, которое иногда включало и десерт — фрукты и т. п. Они имели возможность достаточно спать, им давали витамины. Пленные должны были как можно скорее восстановить силы и стать физически здоровыми.
Получавшие обильное питание «бревна» быстро поправлялись, работы у них не было никакой. С того момента, как их начинали использовать для опытов, их ожидала или верная смерть, или же страдания, сравнимые только с муками ада. А до этого тянулись ничем не заполненные дни, похожие один на другой. «Бревна» томились от вынужденного безделья.
Но дни, когда их хорошо кормили, проходили быстро.
Циркуляция «бревен» была весьма интенсивной. В среднем через каждые два дня три новых человека становились подопытным материалом.
Позже хабаровский судебный процесс по делу бывших военнослужащих японской армии, основываясь на показаниях подсудимого Кавасимы, зарегистрирует в своих документах, что за период с 1940-го по 1945 год «отрядом 731» было «потреблено» не менее трех тысяч человек. В действительности это число было еще больше, — единодушно свидетельствовали бывшие сотрудники отряда.
В Квантунской армии высоко ценили специальные секретные задания, которые выполнял «отряд 731», и принимали все меры для обеспечения его исследовательской работы всем необходимым.
К числу этих мер относилось и бесперебойное снабжение «бревнами».
Людям, когда подходила их очередь становиться подопытными, прививали бактерии чумы, холеры, тифа, дизентерии, cпирохету сифилиса и другие культуры живых бактерий. Их вводили в организм с пищей или каким-либо другим способом. Велись также эксперименты по обморожению, заражению газовой гангреной, проводились расстрелы в опытных целях».
Сэйити Моримуре в результате долгой и кропотливой работы удалось собрать, наверное, самый полный список проводимых в «отряде 731» экспериментов. Читая их краткое описание, понимаешь, как далеко может зайти исследование человеческих возможностей. И от этого описания волосы встают дыбом.
<Изуверские вскрытия живых людей проводились в отряде для ответа на следующие вопросы: когда человек подвергается эпидемическому заражению, увеличивается его сердце или нет, как изменяется цвет печени, какие изменения происходят в живой ткани каждой части тела?
Другой целью вскрытия живого человека было изучение различных изменений, возникавших во внутренних органах после того, как «бревнам» вводили внутрь те или иные химические вещества. Какие процессы происходят в органах при введении воздуха в вены? То, что это влечет за собой смерть, было известно, но сотрудников отряда интересовали более детальные процессы. Через сколько часов и минут наступит смерть, если «бревно» подвесить вниз головой, как изменяются при этом различные внутренние органы? Проводились и такие опыты: людей помещали в центрифугу и вращали с большой скоростью, пока не наступала смерть. Как отреагирует человеческий организм, если в почки ввести мочу или кровь лошади? Проводились опыты по замене человеческой крови кровью обезьян или лошадей. Выяснялось, какое количество крови можно выкачать из одного «бревна». Кровь выкачивали с помощью насоса. Из человека в буквальном смысле выжимали все. Что происходит, когда легкие человека заполняются дымом? Что будет, если дым заменить ядовитым газом? Какие изменения произойдут, если ввести в желудок живого человека ядовитый газ или гниющую ткань?»
Садистов в белых халатах интересовало многое. Осененные очередной дьявольской мыслью, «медики» звонили в тюрьму и делали заказ: «Подберите на ваше усмотрение здоровых «бревен» любого телосложения и пришлите 20 штук». Каждого из них ждал настоящий ад.
— В вакуумную барокамеру поместили подопытного и стали постепенно откачивать воздух, — вспоминает один из стажеров. — По мере того как разница между наружным давлением и давлением во внутренних органах увеличивалась, у него сначала вылезли глаза, потом лицо распухло до размеров большого мяча, кровеносные сосуды вздулись как змеи, а кишечник стал выползать наружу. Наконец человек просто заживо взорвался…
Все это снималось на кинопленку — так определили потолок высоты для летчиков.
В тот период среди солдат Квантунской армии было довольно много случаев обморожения. В отряде хотели как можно скорее собрать данные о процессе обморожения, методах его лечения, а также о том, как протекает бактериальное заражение в условиях сильных морозов.
— Эксперименты по обмораживанию проводились в отряде с ноября по март, — рассказывает очевидец. — При температуре ниже минус 20 подопытных людей выводили ночью во двор, заставляли опускать оголенные руки или ноги в бочку с холодной водой, а потом ставили под искусственный ветер до тех пор, пока они не получали обморожение. После небольшой палочкой стучали по рукам, пока они не издавали звук дощечки…
Свидетели вспоминают, что руки подопытных отнимались буквально на глазах: вначале белели, потом краснели, покрывались волдырями. Наконец кожа чернела и наступал паралич. Лишь тогда мучеников возвращали в теплое помещение и оттаивали водой. Если ее температура была выше плюс 15, омертвевшая кожа и мышцы отваливались, обнажались кости. Спасти от гангрены теперь могла только ампутация изуродованных конечностей.
Кого-то постигла другая ужасная участь: их заживо превращали в мумии — помещали в жарко натопленную комнату с низкой влажностью. Человек обильно потел, но ему не давали пить, пока он полностью не высыхал. Затем тело взвешивали, при этом оказывалось, что весит оно около 22 процентов от первоначального. Именно так в «отряде 731» было сделано еще одно «открытие»: человеческое тело на 78% состоит из воды.
Несмотря на то что в отряде работал целый отдел, скрупулезно фиксировавший на кино- и фотопленку все стадии каждого эксперимента, эти свидетельства практически полностью были уничтожены. Но страдания людей, погибавших мучительной смертью, очень точно и натуралистично переданы объемными «иллюстрациями» опытов над людьми, которые мы сквозь стекло рассматривали в мрачных коридорах «отряда 731».
Окончание следует.
baik-info.ru
Что вы знаете о Японцаx? Не для слабонервныx! Фабрика смерти – Отряд 731

Что вы знаете о Японцаx? Не для слабонервныx! Фабрика смерти – Отряд 731
Прошла и идёт информационная волна о переселении Японцев в Россию и это как вы понимаете далеко не совпадение. Поражает, что некоторые «наивно-добродушные» на форумаx встречал говорят, мол мы не против, они ж xорошие люди, работящие, теxнологичные и т.п.
Вот пример, типа 100 фактов о японцах, и слюнями в комментаx исxодят, мол «xачу в японию!». Но у меня вопрос! А что вообще, кроме ТВ стереотипов, мы знаем о японцаx? О иx культурной традиции? Об иx истории? Знаете ли вы, почему иx лютой ненавистью ненавидят Китайцы и Корейцы? Вот наткнулся на статью, о японском Отряде 731, от которой у меня просто кровь в жилаx стынет. Предупреждаю, СЛАБОНЕРВНЫМ ЛУЧШЕ ЭТОТ ПОСТ НЕ ЧИТАТЬ!!! Это просто ужас! Всё чем вас пугал официоз о зверстваx немецкиx фашистов это детские забавы и гуманизм, по сравнению с японской массовой расчлениловкой. В полностью ебанутыx фильмаx, такиx как «Пила» таким не занимаются, чем занимались Японцы.«Мы считали, что “бревна” — не люди, что они даже ниже скотов. Впрочем, среди работавших в отряде ученых и исследователей не было никого, кто хоть сколько-нибудь сочувствовал “бревнам”. Все — и военнослужащие, и вольнонаемные отряда — считали, что истребление “бревен” — дело совершенно естественное»
Видя такое, начинешь чётко осознавать, что не всё так просто, есть человекоподобные с нечеловеческим нутром, это генетически разные виды. Ну не верю я, что одинаковые с виду Японцы, могли и могут относится к таким же с виду Китайцам, Корейцам как к животным, да и только к ним, ко всем остальным. Вот точно такой же иверской философией страдал Японский император и его подданые:
Наша раса это Сверх Раса. Мы могущественные боги на этой планете. Мы отличаемся от низших рас, как они от насекомых. В самом деле, по сравнению с нашей расой, другие расы звери и животные, крупный рогатый скот в лучшем случае. Другие расы считаются человеческими экскрементами. Это наше предназначение господствовать над низшеими расами. Наше земное царство будет управляться железной рукой нашего лидера. Массы будут лизать ноги и служить нам в качестве рабов
За зверства над Китайцами, Японцы и по сей день не извинились за массовые убийства в Нанкине 1937-38. Но это и не удивительно, когда и перед кем иверы, включая японскиx, извинялись? Нью-Йорксий Ивер Бронштейн-Тоцкий занимался тем же, топил всеx в крови! И где извинения? О чём вы! Xуцпа! Нас же и заставляют извинятся и де-советизироваться и де-сталинизироваться. Вернёмся к японцам! Далее привожу отрывок статьи Филатова, которого надо уметь читать, но по фактологии у него всё верно.Читаем:
Гайдар выполнил план Бжезинского – зачистить от русскиx русский Север и Дальний Восток. По плану Бжезинского – это територии для японцев, на ПМЖ.
Однако есть большой вопрос: как посмотрят на японцев – этих новых незваных соседей, китайцы и корейцы? От японцев они отбиваются, как от чумы и холеры, фигурально и реально травили их дустом и политанью, живьем тысячами закапывали в котлованы и километровые траншеи. Бабий Яр японцы творили в каждой китайской и корейской деревне. (Это всё не преувеличения! Погуглите на тему скажем о Nanking Massacre: http://www.nanking-massacre.com/), http://www.nanking-massacre.com/Photo_pictures_Gallery_exhibition.html это УЖАС, эти самураи, мать иx так, соревнавались кто больше отрубит голов, резали всеx, стариков, женщин, детей, вспарывали животы беременным… это ПЦ!!!! Подxод был тот же, алиенский. Кругом не люди, животные, свиньи, иx можно резать! Есть за что китайцам не то что не любить японцев, а просто ненавидеть) Напонимаю, официально никто толком не извинился. Вроде премьер как то извинился перед китайцами и сразу же давай дома поздравлять теx самыx самураев-головорезов как нац. героев! Всё таже двуликая змеиная алиенская натура!
«Отряд 731»
«Недавно наткнулась на фильм «Философия ножа», про так называемый отряд 731, который действовал на территории Китая во времена Второй мировой войны. Отряд проводил опыты на людях в поисках биологического оружия.
Не люди
Отряд был размещен в 1936 году около деревни Пинфан к юго-востоку от Харбина (на тот момент территория марионеточного государства Маньчжоу-го). Он располагался на территории шесть квадратных километров в почти 150 зданиях. Для всего окружающего мира это было Главное управление по водоснабжению и профилактике частей Квантунской армии. В «отряде 731» было все для автономного существования: две электростанции, артезианские скважины, аэродром, железнодорожная ветка. Была даже своя истребительная авиация, которая должна была сбивать все воздушные объекты (даже японские), которые без разрешения пролетали над территорией отряда. В отряд шли выпускники самых престижных японских университетов, цвет японской науки.
Отряд разместили в Китае, а не в Японии, по нескольким причинам. Во-первых, при дислокации его на территории метрополии очень сложно было соблюсти режим секретности. Во-вторых, в случае утечки материалов пострадало бы китайское население, а не японское. Наконец, в-третьих, в Китае всегда были под рукой «бревна». «Бревнами» офицеры и ученые подразделения называли тех, на ком испытывались смертоносные штаммы: китайских пленных, корейцев, американцев, австралийцев. Среди «бревен» было очень много наших соотечественников — белоэмигрантов, которые жили в Харбине. Когда запас «подопытных» в отряде подходил к концу, доктор Исии обращался к местным властям с просьбой о новой партии. Если под рукой у тех не было военнопленных, японские спецслужбы совершали рейды по ближайшим китайским населенным пунктам, пригоняя на «водоочистительную станцию» захваченных гражданских.
Первое, что делали с новичками, — откармливали. У «бревен» было трехразовое питание и даже иногда десерты с фруктами. Подопытный материал должен был быть абсолютно здоровым, дабы не нарушать чистоту эксперимента. Согласно инструкциям, любой сотрудник отряда, который посмел бы назвать «бревно» человеком, сурово наказывался.
«Мы считали, что “бревна” — не люди, что они даже ниже скотов. Впрочем, среди работавших в отряде ученых и исследователей не было никого, кто хоть сколько-нибудь сочувствовал “бревнам”. Все — и военнослужащие, и вольнонаемные отряда — считали, что истребление “бревен” — дело совершенно естественное», — говорил один из служащих.
«Они были для меня бревнами. Бревна нельзя рассматривать как людей. Бревна уже мертвые сами по себе. Теперь они умирали второй раз, и мы лишь исполняли смертный приговор», — говорил специалист по обучению персонала «отряда 731» Тошими Мизобучи.
В поисках чудо-оружия
Профильными экспериментами, которые ставились над подопытными, были испытания эффективности различных штаммов болезней. «Фавориткой» Исии была чума. Ближе к концу войны он вывел штамм чумной бактерии, в 60 раз превосходящий по вирулентности обычную. Эти бактерии хранились в сухом виде, а непосредственно перед использованием достаточно было лишь смочить их водой и небольшим количеством питательного раствора.
Эксперименты по выведению этих бактерий проводились над людьми. Например, в отряде были специальные клетки, куда запирали людей. Клетки были настолько маленькими, что пленники не могли пошевелиться. Их заражали какой-либо инфекцией, а затем днями наблюдали над изменениями состояния организма. Были и клетки побольше. Туда загоняли одновременно больных и здоровых, дабы отследить, насколько быстро болезнь передается от человека к человеку. Но каким бы образом его ни заражали, сколько бы ни наблюдали, конец был один — человека заживо препарировали, вытаскивая органы и наблюдая, как болезнь распространяется внутри. Людям сохраняли жизнь и не зашивали их целыми днями, дабы доктора могли наблюдать за процессом, не утруждая себя новым вскрытием. При этом никакой анестезии обычно не использовалось — врачи опасались, что она может нарушить естественный ход эксперимента.
Больше «повезло» тем, на ком испытывали не бактерии, а газы. Они умирали быстрее. «У всех подопытных, погибших от цианистого водорода, лица были багрово-красного цвета, — рассказывал один из служащих отряда. — У тех, кто умирал от иприта, все тело было обожжено так, что на труп невозможно было смотреть. Наши опыты показали, что выносливость человека приблизительно равна выносливости голубя. В условиях, в которых погибал голубь, погибал и подопытный человек».
Испытания биологического оружия проходили не только у Пинфаня. Помимо собственно основного здания «отряд 731» имел четыре филиала, расположенных вдоль советско-китайской границы, и один испытательный полигон-аэродром в Аньда. Туда возили заключенных, чтобы отрабатывать на них эффективность применения бактериологических бомб. Их привязывали к специальным шестам или крестам, вбитым по концентрическим кругам вокруг точки, куда затем сбрасывали начиненные чумными блохами керамические бомбы. Дабы подопытные случайно не умерли от осколков бомб, на них надевали железные каски и щиты. Иногда, впрочем, оставляли голыми ягодицы, когда вместо «блошиных авиабомб» использовались бомбы, начиненные специальной металлической шрапнелью с винтообразным выступами, на которые наносились бактерии. Сами ученые стояли на расстоянии трех километров и наблюдали за подопытными в бинокли. Затем людей везли назад на объект и там, как и всех подобных подопытных, вскрывали заживо, дабы пронаблюдать, как прошло заражение.
Впрочем, один раз такой эксперимент, проводившийся на 40 подопытных, завершился не так, как планировали японцы. Одному из китайцев удалось каким-то образом ослабить путы и спрыгнуть с креста. Он не убежал, а сразу же распутал ближайшего товарища. Затем они бросились освобождать остальных. Только после того, как все 40 человек были распутаны, все бросились врассыпную.
Японские экспериментаторы, увидевшие в бинокли, что происходит, были в панике. Если бы хотя бы один подопытный убежал, то сверхсекретная программа оказалась бы под угрозой. Не растерялся лишь один из охранников. Он сел в машину, помчался наперерез бежавшим и стал их давить. Полигон Аньда представлял собой огромное поле, где на протяжении 10 километров не было ни одного деревца. Поэтому большинство заключенных было раздавлено, а кое-кого даже удалось взять живыми.
Полевые испытания
После «лабораторных» испытаний в отряде и на полигоне научные сотрудники «отряда 731» проводили полевые испытания. С самолета над китайскими городами и селами сбрасывали начиненные чумными блохами керамические бомбы, выпускали чумных мух. В своей книге «Фабрика смерти» историк Калифорнийского государственного университета Шэлдон Хэррис утверждает, что от чумных бомб погибло более 200 тысяч человек.
Достижения отряда широко использовались и для борьбы с китайскими партизанами. Например, штаммами с брюшным тифом заражались колодцы и водоемы в местах, которые контролировали партизаны. Однако вскоре от этого отказались: часто под удар подпадали собственные войска.
Впрочем, японские военные уже убедились в эффективности работы «отряда 731»и стали разрабатывать планы применения бактериологического оружия против США и СССР. С боеприпасами проблем не было: по рассказам сотрудников, к концу войны в запасниках «отряда 731» накопилось столько бактерий, что если бы они при идеальных условиях были рассеяны по земному шару, этого оказалось бы достаточно, чтобы уничтожить все человечество. Но японскому истеблишменту не хватило политической воли — а может, хватило трезвости…
В июле 1944 года лишь позиция премьер-министра Тодзе спасла Соединенные Штаты от катастрофы. Японцы планировали с помощью воздушных шаров переправить на американскую территорию штаммы различных вирусов — от смертельных для человека до тех, которые будут губить скот и урожай. Тодзе понимал, что Япония уже явно проигрывает войну и при атаке биологическим оружием Америка может ответить тем же.
Несмотря на оппозицию Тодзе, японское командование в 1945 году до самого конца разрабатывало план операции «Вишня расцветает ночью». Согласно плану, несколько подлодок должно было подойти к американскому берегу и выпустить там самолеты, которые должны были распылить над Сан-Диего инфицированных чумой мух. По счастью, к тому моменту у Японии было максимум пять подлодок, каждая из которых могла нести по два-три специальных самолета. И руководство флота отказалось предоставить их для операции, мотивировав это тем, что все силы необходимо сконцентрировать на защите метрополии.
122 по Фаренгейту
Сотрудники «отряда 731» по сей день утверждают, что испытания биологического оружия на живых людях было оправданным. «Нет гарантии, что подобное никогда не повторится, — говорил с улыбкой в интервью New York Times один из участников этого отряда, встречавший свою старость в японской деревне. — Потому что в войне вам всегда надо побеждать».
Рабочий момент в отряде 731
Но дело в том, что самые страшные эксперименты, проводившиеся на людях в отряде Исии, не имели никакого отношения к биологическому оружию. Особо бесчеловечные опыты ставились в самых засекреченных помещениях отряда, куда даже не имела доступа большая часть обслуживающего персонала. Они имели исключительно медицинское предназначение. Японские ученые хотели знать пределы выносливости человеческого организма.
Цех исследований отморожений и ожогов
Например: солдаты императорской армии в Северном Китае зимой часто страдали от обморожения. «Опытным путем» доктора из «отряда 731» выяснили, что лучшим способом лечить обморожение было не растирание пострадавших конечностей, а погружение их в воду с температурой от 100 (37C) до 122 (50C) градусов по Фаренгейту. Чтобы это понять, «при температуре ниже минус 20 подопытных людей выводили ночью во двор, заставляли опускать оголенные руки или ноги в бочку с холодной водой, а потом ставили под искусственный ветер до тех пор, пока они не получали обморожение, — рассказывал бывший сотрудник отряда. — После небольшой палочкой стучали по рукам, пока они не издавали звук как при ударе о деревяшку». Затем обмороженные конечности клали в воду определенной температуры и, изменяя ее, наблюдали за отмиранием мышечной ткани на руках.
Среди таких подопытных был и трехдневный ребенок: дабы он не сжимал руку в кулачок и не нарушил чистоту эксперимента, ему воткнули в средний палец иголку.
Для императорских ВВС проводились эксперименты в барокамерах. «В вакуумную барокамеру поместили подопытного и стали постепенно откачивать воздух, — вспоминал один из стажеров отряда. — По мере того как разница между наружным давлением и давлением во внутренних органах увеличивалась, у него сначала вылезли глаза, потом лицо распухло до размеров большого мяча, кровеносные сосуды вздулись как змеи, а кишечник, как живой, стал выползать наружу. Наконец человек просто заживо взорвался». Так японские врачи определяли допустимый высотный потолок для своих летчиков.
Кроме того, для выяснения наиболее быстрого и эффективного способа лечить боевые ранения людей взрывали гранатами, расстреливали, сжигали из огнеметов…
Были и эксперименты просто для любопытства. У подопытных вырезали из живого тела отдельные органы; отрезали руки и ноги и пришивали назад, меняя местами правые и левые конечности; вливали в человеческое тело кровь лошадей или обезьян; ставили под мощнейшее рентгеновское излучение; оставляли без еды или без воды; ошпаривали различные части тела кипятком; тестировали на чувствительность к электротоку. Любопытные ученые заполняли легкие человека большим количеством дыма или газа, вводили в желудок живого человека гниющие куски ткани.
Впрочем, из подобных «бесполезных» экспериментов получался и практический результат. Например, так появилось заключение о том, что человек на 78% состоит из воды. Чтобы это понять, ученые сначала взвесили пленника, а затем поместили его в жарко натопленную комнату с минимальной влажностью. Человек обильно потел, но ему не давали воды. В итоге он полностью высыхал. Затем тело взвешивали, при этом оказывалось, что весит оно около 22% от первоначальной массы.
Набить руку
Наконец, японские хирурги просто набивали руку, тренируясь на «бревнах». Один из примеров подобной «тренировки» описывается в книге «Кухня дьявола», написанной самым известным исследователем «отряда 731» Сэйити Моримурой.
«В 1943 году в секционную привели китайского мальчика. По словам сотрудников, он не был из числа “бревен”, его просто где-то похитили и привезли в отряд, но точно ничего известно не было. Мальчик разделся, как ему было приказано, и лег на стол спиной. Тотчас же на лицо ему наложили маску с хлороформом. Когда наркоз окончательно подействовал, все тело мальчика протерли спиртом. Один из опытных сотрудников группы Танабэ, стоявших вокруг стола, взял скальпель и приблизился к мальчику. Он вонзил скальпель в грудную клетку и сделал разрез в форме латинской буквы Y. Обнажилась белая жировая прослойка. В том месте, куда немедленно были наложены зажимы Кохера, вскипали пузырьки крови. Вскрытие заживо началось. Из тела мальчика сотрудники ловкими натренированными руками один за другим вынимали внутренние органы: желудок, печень, почки, поджелудочную железу, кишечник. Их разбирали и бросали в стоявшие здесь же ведра, а из ведер тотчас же перекладывали в наполненные формалином стеклянные сосуды, которые закрывались крышками. Вынутые органы в формалиновом растворе еще продолжали сокращаться. После того как были вынуты внутренние органы, нетронутой осталась только голова мальчика. Маленькая, коротко остриженная голова. Один из сотрудников группы Минато закрепил ее на операционном столе. Затем скальпелем сделал разрез от уха к носу. Когда кожа с головы была снята, в ход пошла пила. В черепе было сделано треугольное отверстие, обнажился мозг. Сотрудник отряда взял его рукой и быстрым движением опустил в сосуд с формалином. На операционном столе осталось нечто, напоминавшее тело мальчика, — опустошенный корпус и конечности».
В этом «отряде» не было никаких «отходов производства». После экспериментов с обморожением покалеченные люди шли на опыты в газовые камеры, а органы после экспериментальных вскрытий поступали в распоряжение микробиологов. Каждое утро на специальном стенде висел перечень того, в какой отдел пойдут какие органы от намеченных к вскрытию «бревен».
Все опыты тщательно документировались. Помимо кипы бумаг и протоколов в отряде было около 20 кино— и фотокамер. «Десятки и сотни раз мы вдалбливали себе в голову, что подопытные не люди, а всего лишь материал, и все равно при вскрытиях заживо у меня мутилось в голове, — рассказывал один из операторов. — Нервы нормального человека этого не выдерживали».
Некоторые опыты фиксировал на бумаге художник. В то время существовала лишь черно-белая съемка, и она не могла отразить, например, изменение цвета ткани при обморожении…
Оказались востребованы.
По воспоминаниям сотрудников «отряда 731», всего за время его существования в стенах лабораторий погибло около трех тысяч человек. Но некоторые исследователи утверждают, что реальных жертв было гораздо больше.
Конец существованию «отряда 731» положил Советский Союз. 9 августа советские войска начали наступление против японской армии, и «отряду» было приказано «действовать по собственному усмотрению». Работы по эвакуации начались в ночь с 10 на 11 августа. Важнейшие материалы — описания применения бактериологического оружия на территории Китая, кипы протоколов вскрытий, описания этиологии и патогенеза, описания процесса культивирования бактерий — сжигали в специально вырытых ямах.
Было решено уничтожить и остававшиеся на тот момент в живых «бревна». Часть людей отравили газом, а некоторым было благородно позволено покончить жизнь самоубийством. Трупы сбросили в яму и сожгли. Первый раз сотрудники отряда «схалтурили» — трупы сгорели не до конца, и их просто забросали землей. Прознав об этом, начальство, несмотря на спешку эвакуации, приказало трупы выкопать и сделать работу «как надо». После второй попытки пепел и кости были сброшены в реку Сунгари.
Туда же были выброшены и экспонаты «выставочной комнаты» — огромного зала, где в наполненных специальным раствором колбах хранились отрезанные человеческие органы, конечности, разрубленные разным способом головы, препарированные тела. Часть из этих экспонатов были зараженными и демонстрировали различные этапы поражения органов и частей тела человека. Выставочная комната могла бы стать самым наглядным доказательством бесчеловечной сущности «отряда 731». «Недопустимо, чтобы в руки наступающих советских войск попал хотя бы один из этих препаратов», — заявило руководство отряда подчиненным.
Но часть наиболее важных материалов была сохранена. Их вывезли Сиро Исии и некоторые другие руководители отряда, передав все это американцам — как своего рода выкуп за свою свободу. Для США эта информация имела чрезвычайную важность.
Американцы начали свою программу развития биологического оружия лишь в 1943 году, и результаты «полевых опытов» их японских визави оказались как нельзя кстати.
«В настоящее время группа Исии, тесно сотрудничая с США, готовит большое количество материалов для нас и дала согласие предоставить в наше распоряжение восемь тысяч слайдов, на которых запечатлены животные и люди, подвергшиеся бактериологическим экспериментам, — говорилось в специальном меморандуме, распространенном среди избранных лиц госдепартамента и Пентагона. — Это крайне важно для безопасности нашего государства, и ценность этого значительно выше того, чего мы достигли бы, возбудив судебное расследование военных преступлений… В связи с чрезвычайной важностью информации о бактериологическом оружии японской армии правительство США решает не обвинять в военных преступлениях ни одного сотрудника отряда по подготовке бактериологической войны японской армии».
Поэтому в ответ на запрос советской стороны о выдаче и наказанию членов отряда в Москву было передано заключение о том, что «местопребывание руководства “отряда 731”, в том числе Исии, неизвестно и обвинять отряд в военных преступлениях нет оснований».
В целом в «отряде 731» работало почти три тысячи ученых (включая тех, кто трудился на вспомогательных объектах). И все они кроме тех, кто попал в руки СССР, избежали ответственности. Многие из ученых, препарировавших живых людей, стали в послевоенной Японии деканами университетов, медучилищ, академиками, бизнесменами. Среди них были губернатор Токио, президент японской медицинской ассоциации, высокопоставленные сотрудники Национального института здравоохранения. Военные и врачи, которые работали с «бревнами»-женщинами (в основном экспериментировали с венерическими заболеваниями), после войны открыли частный родильный дом в районе Токай.
Принц Такеда (двоюродный брат императора Хирохито), который инспектировал «отряд», тоже не понес наказания и даже возглавил японский Олимпийский комитет в преддверии Игр 1964 года. А сам злой гений отряда — Сиро Исии — безбедно жил в Японии и умер от рака в 1959 году.
Слабонервным людям с хрупкой психикой настоятельно не рекомендуеться смотреть фильм «Философия ножа«!!!»
Мы с вами особенно запомни вот это:
«…японские военные уже убедились в эффективности работы «отряда 731» и стали разрабатывать планы применения бактериологического оружия против США И СССР…
В июле 1944 года лишь позиция премьер-министра Тодзе спасла Соединенные Штаты от катастрофы. Японцы планировали с помощью воздушных шаров переправить на американскую территорию штаммы различных вирусов — от смертельных для человека до тех, которые будут губить скот и урожай. Тодзе понимал, что Япония уже явно проигрывает войну и при атаке биологическим оружием Америка может ответить тем же».
Автор, написавший, что будто бы «Тодзе понимал, что Япония уже явно проигрывает войну и при атаке бактериологическим оружием Америка может ответить тем же, потому, мол, японцы и не ударили по США бактериологическим, автор этот или дурака валяет, или японцы ему за эти слова хорошо заплатили. Самураи до последней секунды не сомневались, верили, что они победят. А не ударил они бактериологическими бомбами по США:
во-первых, у японцев не было надежной доставки бомб — воздушные шары очень даже могли полететь совсем в другую сторону,
во-вторых, у японцев не было достаточного количества бактериологических бомб, чтобы, после атаки на США, американцы не способны были бы ни на какой ответный удар по Японии, никаким оружием. Да и не было у американцев такого высочайшего качества бактериологическое оружие, какое было у японцев. У американцев его было в мизерных количествах и очень слабенькое по убойной силе, в сравнении с японским, потому, а не из вредности, американцы ударили по японским людоедам тем, что имели на тот момент под рукой – атомными бомбами.
Запомним!
и нападение японцев на мирно стоявшие американские корабли в бухте Перл-Харбор, и уничтожение их полностью, и, как японцы вырезали печень почти у каждого американского военнопленного и съедали её тут же…
Атомной бомбардировкой Японии, применением атомного оружия массового поражения, американцы всего лишь, опередили японцев, которые в любую минуту могли нанести удар по США оружием массового поражения – бактериологическим, не атомными, а альтернативными – бактериологическими бомбами. Так, может, в последний момент американцы успели спастись от страшной и неминуемой поголовной смерти от японцев. А заодно и спасли всех нас? Всё человечество? Гитлеру ведь то же не хватило, каких-то недель до получения «оружия возмездия».
Зная, хотя бы эту самую малость о стране — «Отряд 731», может, не порицать Америку за бомбежку Хиросимы и Нагасаки, а наоборот -сказать спасибо?
Мы из всего делаем политику. Японцы ни из чего такого политику не делают.
«Отношение оппозиции к действиям кабинета показывает: в Японии не принято зарабатывать политические очки на трагедии… Вот такая она, демократия японской сборки», — сообщает очень информированный «Коммерсант», по крайне мере – делает вид, что – суппер информированный.
Мы все для японцев — «брёвны», которые подлежат разделкe: или на доски, или в стружку. И японцы работают на это дружно, как мураши. И вся – политика.
Дело не в том, что у людей там нет веры, а в том, что в душе у них – безбожье. Они ведут себя так, будто забывают, что кроме них живет еще кто-то на земле.
Заранее могу сказать: не сносить головы Медведеву, если он от «базара» о приглашении японцев на земли России, перейдет к делу.
Кстати, сейчас Медведев из кожи вон лезет об улучшения «инвестиционного климата» в экономику России.
«Медведев утвердил перечень поручений, направленных на улучшение инвестиционного климата в России», — сообщает в субботу пресс-служба Кремля.
В частности, глава государства поручил правительству РФ до 15 мая утвердить график приватизации находящихся в федеральной собственности крупных пакетов акций на 2011-2013 годы, — сообщает в субботу пресс-служба Кремля…»
Но весь мир знает, что иностранные инвестиции – это форма оккупации. В Германии не так давно принят закон, запрещающий намертво какие-либо иностранные инвестиции в свою экономику. У Меркель хватило ума и смелости, так и сказать: иностранные инвестиции в нашу экономику – это оккупация, мы этого не допустим.
newspark.net.ua
Кухня дьявола № 731: опыты над живыми людьми
Начало в № 5(309)
К 1945 году Япония была практически готова к нанесению мощного бактериологического удара по дальневосточным и сибирским территориям Советского Союза. В строго засекреченном подразделении Квантунской армии — «отряде 731», расположенном в Маньчжурии, — уже были созданы огромные запасы бактерий, способных вызвать массовые эпидемии. Но Советская армия, буквально сметая самураев, закрыла эту жуткую страницу истории. «Отряд 731» за несколько дней до прихода советских войск в панике эвакуировался из Харбина. Наш корреспондент, побывавший недавно на месте тех событий, продолжает свой рассказ.
ВНИМАНИЕ! МАТЕРИАЛ НЕ РЕКОМЕНДУЕТСЯ ЧИТАТЬ ДЕТЯМ, А ТАКЖЕ ЛЮДЯМ СО СЛАБОЙ ПСИХИКОЙ.
Возвращаясь к первой части этой публикации, повторюсь, что, бродя по слабоосвещенным коридорам уцелевших корпусов «отряда 731», которые превращены теперь во вполне цивильный музей, я не подозревал, какие события происходили здесь более 60 лет назад. А китаянка-экскурсовод заученными фразами на русском вряд ли смогла бы передать то ощущение ужаса, которое впитали эти стены. Стены, где были зверски замучены более трех тысяч человек — пленных красноармейцев, китайских солдат, местных патриотов, журналистов, просто мирных граждан, крестьян, случайно арестованных в Харбине или похищенных в окрестных деревнях. Мужчин, женщин, детей, грудных детей…
Но это удалось японскому публицисту Сэйити Моримуре в книге «Кухня дьявола», в которой он на основе найденных документов и интервью с участниками тех событий бесстрастно восстанавливает жуткую историю крупнейшего в мире завода по разработке и производству бактериологического оружия. Эту страшную книгу трудно читать.
Интересы Папаши Исии
Генерала Сиро Исии, начальника «отряда 731», главного идеолога бактериологической войны против Советского Союза, придумавшего использовать живых людей в своих дьявольских опытах, сослуживцы за глаза называли обезьяной. Сэйити Моримура в своей книге «Кухня дьявола» приводит воспоминания одного из них: «Папаша Исии был самой хитрой из всех обезьян, ученой обезьяной».
— Еще будучи преподавателем военно-медицинской академии в Японии, — рассказывает другой очевидец, — Исии использовал для опытов живых людей — своих помощников. Известно, что несколько человек, работавших над исследованием бактерий в качестве помощников Исии, умерло от бактериального заражения. Среди сравнительно небольшого числа острых эпидемических заболеваний Исии больше всего внимания уделял чуме. Сейчас уже трудно установить, от каких болезней погибли помощники Исии, но, думаю, это была чума.
На бактериях чумы, как самого мощного оружия, Исии остановился не случайно. Из своих шпионских поездок по Европе в начале 30-х годов он привез главную новость: все европейские страны (даже фашистская Германия!) исключили бактерии чумы из числа бактериальных средств, которые могут быть использованы в качестве оружия. Уж слишком велик был ужас европейцев, связанный с эпидемиями чумы, который передавался там из поколения в поколение.
Но интересы Папаши Исии были разносторонними. В его лабораториях, кроме чумы, изучали и разводили бактерий тифа, холеры, дизентерии, столбняка, туберкулеза, сибирской язвы, проказы — таков был ассортимент продукции этой «фабрики».
Моримуре удалось полностью восстановить процесс производства этих смертоносных бактерий. Процесс этот целиком был поставлен на поток и проходил в специальных стерильных помещениях. Лица сотрудников закрывали маски. Никого узнать было невозможно. Чтобы не вдохнуть живые бактерии, они не произносили ни слова и объяснялись только жестами. Белые шапочки, белые халаты, фартуки, большие очки — медленно двигавшиеся безмолвные фигуры производили таинственное впечатление.
Бактерий разводили на агар-агаре — продукте, получаемом из красных и бурых водорослей. После завершения посева питательная среда перемещалась в культивационную камеру. Получив освещение нужной интенсивности, необходимую температуру и агар-агар для питания, бактерии быстро размножались, образуя молочно-белые скопления на поверхности питательной среды. По истечении определенного времени сотрудники группы начинали сбор бактерий. Скопления бактерий соскребали в специальные химические стаканы.
«На дне химического стакана находились бактерии в виде молочно-белой массы, напоминавшей сусло для приготовления японской сладкой саке (рисовая водка. — Прим. авт.)», — вспоминал один из бывших сотрудников этой лаборатории.
Атака чумных блох
Но по замыслу Исии для использования бактериальных средств в войне необходимы были переносчики болезнетворных микроорганизмов. Наиболее эффективные переносчики чумы — блохи. Если заразить бактериями большое количество блох и рассеять их в нужном месте, то в довольно короткий срок можно вызвать чумную эпидемию. Осуществлением этой идеи и занялись экспериментаторы.
Из материалов судебного процесса над убийцами в белых халатах, который состоялся в Хабаровске в конце декабря 1949 года:
«Подопытные люди, использовавшиеся для этих экспериментов, в количестве 15 человек были доставлены из внутренней тюрьмы отряда и привязаны на территории, где производился опыт, к специально врытым в землю столбам… Специальный самолет сбросил на полигон около двух десятков бомб, которые, не долетев до земли от 100 до 200 метров, разорвались, из них выпали чумные блохи, которыми были начинены бомбы. Эти чумные блохи распространились по всей территории.
После того как бомбометание было произведено, выждали значительный промежуток времени, для того чтобы блохи могли распространиться и заразить подопытных людей».
О многочисленных экспериментах с керамическими бомбами, начиненными блохами, вспоминает один из бывших служащих отряда:
«Для того чтобы насекомые добрались до «бревен» и начали сосать их кровь, требовалось четыре-пять часов. «Бревна», видя, как несметное количество блох сначала впивается им в ноги, а затем распространяется по всему телу, отчаянно бились и кричали, но, поскольку их руки и ноги были привязаны к столбам, они ничего сделать не могли. В каждой бомбе находилось около 30 тысяч блох».
Из тканей умерших людей выделяли микробы с самой высокой активностью и передавали в производственные помещения отряда.
Моримура пишет: «На полигоне близ станции Аньда проводились многочисленные эксперименты как с целью усовершенствовать керамические бомбы, так и с целью найти способы повышения активности чумных блох».
На полигоне были врыты в землю столбы на расстоянии 5-10 метров один от другого. К ним привязывали людей, тела которых полностью защищались одеялами и металлическими щитами.
Для совершенствования бактериологического оружия и определения его эффективности необходимо было взрывать бомбы под разными углами к земле и на разной высоте. Это давало возможность получить точные данные о зависимости между точкой взрыва бомбы и районом бактериального заражения.
Если бы подопытные оказались раненными осколками бомб или артиллерийских снарядов и это явилось бы причиной их смерти, весь смысл эксперимента свелся бы к нулю. Необходимо было установить точный коэффициент смертности именно от бактериального заражения. С этой целью и применялись одеяла и щиты.
Привязанных к столбам людей подвергали самым разнообразным экспериментам. Иногда у десятка-другого оставляли обнаженными только ягодицы и проводили опыт по заражению возбудителями газовой гангрены.
На предельно близком расстоянии от подопытных взрывали бомбы со шрапнелью, зараженной возбудителями газовой гангрены. Бесчисленные осколки впивались людям в обнаженные ягодицы. Подопытные кричали от нестерпимой боли, в то время как сотрудники отряда хладнокровно обследовали их, пытаясь выяснить, попали бактерии газовой гангрены в цель или нет.
После этого людей возвращали в специальную тюрьму отряда. Там тщательно наблюдали за развитием болезни — вплоть до наступления смерти. Помощи им не оказывали никакой. О помощи не могло быть и речи, ведь экспериментаторов интересовал именно процесс непрерывного размножения бактерий и разрушения ими человеческого организма. По прошествии недели подопытные, от которых исходило ужасающее зловоние, умирали.
Все эти эксперименты фиксировались на кинопленку.
Бывший служащий отряда рассказывает: «Эксперименты по заражению газовой гангреной проводились многократно. И не только эти… Проводились также эксперименты с применением бактериологического пистолета в форме авторучки, ставились и более простые опыты. Например, людям обнажали бедра, вблизи взрывали ручные гранаты и потом изучали, каким образом осколки входят в тело; стреляли в голову под разными углами из винтовки, после чего вынимали и препарировали мозг; иногда людей просто убивали ударом дубины, а затем исследовали поврежденную ткань…»
Информация сквозь толщу стен
Приходится намеренно опускать и не цитировать многие другие места из книги Моримуры, который не просто восстанавливает жуткие подробности «научной работы» изуверов из императорской армии. Публицист честно рисует лицо войны, готовившейся его соотечественниками, рассказывает о людях обреченных, но не сдавшихся.
Какие мысли живут в голове человека, знающего, что через день-два он погибнет в страшных муках?
Люди, заключенные в блоках № 7 и № 8, знали, что им уготована судьба «бревен». Тюремная охрана ничего не могла поделать и понять, как это происходит, но между камерами существовала связь. Сквозь стены толщиной 40 сантиметров передавалась информация. Сотрудники спецгруппы так и не смогли разгадать секрет, назвав это чудом.
Часть заключенных не желали чувствовать себя обреченными, они сохраняли силу духа до последних минут жизни. Как бы бесчеловечно ни относились в отряде к «бревнам», считая их лишь материалом для экспериментов, они все-таки оставались людьми. Скованные по рукам и ногам, заточенные в изолированном пространстве, днем «бревна» копили энергию, лежа на своих подстилках и прячась от глаз охранников. Ночью же в тюрьме начиналась тайная борьба. Из камеры в камеру летели сигналы: люди называли себя, передавали то, что происходило у них.
Был такой случай. С целью эксперимента заключенным раздали сладкие пирожки, зараженные бактериями тифа. Но ни один заключенный к ним не притронулся. Очевидно, те, кто знал о подобных опытах, передали по всем камерам, что пирожки, возможно, заражены бактериями.
Бунт «бревен»
Когда и при каких обстоятельствах в специальной тюрьме отряда произошел бунт «бревен», до сих пор точно ничего не известно. Помнят только, что это было «солнечным днем до полудня» в первой декаде июня 1945 года.
В одной из тюремных камер, находившихся в левом крыле 7-го корпуса на втором этаже, содержалось двое русских заключенных. В то утро один из них стал звать охранника, чтобы объяснить ему, что его товарищ по камере заболел. Служащие отряда остро реагировали на любые изменения самочувствия «бревен» — наблюдение за подопытными было важной частью их повседневной работы.
Когда охранник вошел, то тут же получил мощный удар по переносице цепью от наручников. У обоих узников наручники оказались сняты. «Как они ухитрились снять наручники — над этим потом еще долго все ломали голову, — вспоминает бывший служащий отряда. — То ли им вдвоем удалось сломать наручники, то ли они были специалистами по такого рода устройствам, то ли, наконец, сами наручники были с изъяном».
Завладев ключами, один из русских выбежал в коридор и начал открывать камеры, криками и жестами поднимая узников: «Выходите! Бегите!»
Но бежать было некуда: дверь на лестницу уже была перекрыта подоспевшей спецгруппой. Сам тюремный блок окружили десятки вооруженных японцев — перепугавшаяся охрана вызвала подкрепление. В панике собрали и вооружили даже вольнонаемных сотрудников отряда, занятых на хозработах.
На основе рассказа одного из свидетелей того бунта, которого удалось разговорить, Моримура пишет:
«В левой части коридора один из заключенных, схватившись за решетку, начал что-то громко кричать сотрудникам отряда, целившимся в него. Это был русский, шатен, лет сорока, широкоплечий. Его мощный голос разносился по всему внутреннему двору. Никто из отряда подкрепления не понимал русского языка, но в облике заключенного и в его голосе угадывался протест. Вольнонаемные были ошеломлены гневной речью русского и его энергичными движениями, однако продолжали держать его под прицелом. А переводчик переводил: «Вы нас обманом сюда заключили, проводите зверские опыты и погубили уже много людей… Вы на нас винтовки навели, а нам все равно не страшно… Все японцы трусы… Немедленно освободите нас… Или уж сразу убейте. Это лучше, чем быть морскими свинками для ваших опытов».
Русский, ударяя себя кулаками в грудь, продолжал отважно стоять под дулами винтовок в своей черной одежде с нашитым на ней номером. Возле него столпились и другие заключенные, поддерживавшие его.
Во внутреннем дворе специальной тюрьмы создалась странная ситуация. Люди, которые, казалось, должны были быть парализованы под наведенными на них дулами винтовок, чувствовали себя, однако, все увереннее и одерживали верх над вооруженными до зубов служащими отряда.
Русский, широко раскинув руки и выпрямив грудь, схватился за прутья решетки. Всем своим видом он как бы призывал: «Ну стреляйте же!» Его громкий, уверенный голос и гневные интонации озлобляли служащих отряда.
«А-а, негодяй! Умри!» — с этими словами один из молодых вольнонаемных, у которого сдали нервы, нажал на спусковой крючок…
Вот что рассказывает бывший на месте происшествия служащий отряда: «Когда думаешь об этом теперь, становится ясно, что голос русского был криком души, у которой отняли свободу… Но тогда я не мог правильно понять его гнев. «Бревен» мы людьми не считали. Так как же можно было спокойно отнестись к тому, что они взбунтовались? Однако протест этого русского, то, как он до последнего вздоха стоял, широко расправив плечи, произвело на нас сильное впечатление. Мы заставили его замолчать пулей, но он, безоружный и лишенный свободы, несомненно, был сильнее нас. Тогда мы все в душе почувствовали: правда не на нашей стороне. Когда я вспоминаю все, что произошло тогда, я не могу спать по ночам».
Всех заключенных взбунтовавшегося блока в тот же день через систему вентиляции в камерах умертвили ядовитым газом.
«Увеличить число бактерий, блох и крыс!»
В мае 1945 года генерал Исии отдал распоряжение об увеличении производства, в котором говорилось: «Война между Японией и СССР неизбежна… Отряд должен мобилизовать все силы и в короткий срок увеличить производство бактерий, блох и крыс». Иными словами, стадия экспериментов закончилась, теперь начинается бактериологическая война на практике, нужно наращивать производство в ожидании дня X.
Были уже размножены и географические карты советских дальневосточных районов с указанием населенных пунктов, водоемов и других объектов для бактериологического нападения. Бактериологическое оружие планировалось применить в первую очередь в районе Хабаровска, Благовещенска, Уссурийска, Читы. Сюда намечалось сбрасывать авиабомбы, наполненные чумными блохами, предусматривался также вариант распыления бактерий с самолетов.
К этому времени в отряде уже были разработаны технология высушивания бактерий чумы и способ хранения их в сухом виде, уже производился штамм чумной бактерии, в 60 раз превосходящий по вирулентности обычную. Достигла высокого уровня техника распыления бактерий в виде дождевого облака, была усовершенствована керамическая бомба, в массовом масштабе размножались особо жизнестойкие крысы и обладающие большой кровососущей силой блохи.
В конце войны «готовых к употреблению» бактерий в «отряде 731» хранилось столько, что, как говорил бывший служащий отряда, если бы они при идеальных условиях были рассеяны по земному шару, этого хватило бы, чтобы уничтожить все человечество.
Число крыс было приказано довести до 3 миллионов… Была поставлена задача произвести 300 килограммов чумных блох, то есть около миллиарда особей.
«Конечно, получить миллиард живых, качественных, готовых к использованию блох было делом серьезным. Если бы заразить всех этих блох чумой и разом применить против советских войск, а также обрушить на города — последствия были бы весьма значительные. Это мы все понимали», — говорит бывший служащий отряда.
Однако «вакханалия» бактерий, грызунов и блох, развернувшаяся в «отряде 731″, прекратилась 9 августа 1945 года. На рассвете 9 августа советские войска начали военные действия против Японии».
«Всем служащим покончить жизнь самоубийством!»
Эвакуация «отряда 731» — отдельный рассказ. Бывшие сотрудники отряда сходятся в одном: это были ужасные дни, похожие на кошмарный сон.
Чего стоил только приказ генерала Исии: всему личному составу филиалов «отряда 731», находившихся на пути наступления советских войск, а также членам семей всех служащих покончить жизнь самоубийством, после этого всем оставшимся отступать на юг. И ведь выполнили бы приказ, но другой высокопоставленный генерал, Кикути, заставил Исии его отменить. Однако многим семьям сотрудников все же раздали пузырьки с синильной кислотой.
Отряд ликвидировали в страшной панике. Под весть, что советские войска уже в Чанчуне, загрузили 15 эшелонов по 20 вагонов. Описания экспериментов, препараты, драгоценности (сейчас установлено, что Исии неслабо обворовывал императорскую армию). Но главное, нужно было уничтожить все следы пребывания под Харбином этого секретного подразделения.
Два корпуса, в которых мне пришлось побывать, — это все, что осталось от целого секретного города. В одном месте коридор меньшего из них заканчивается развалинами. Здания отряда взрывали долго с помощью саперов. А до этого уничтожили всех заключенных и сожгли их трупы…
В ночь отправки генерал Исии медленно шел по перрону вдоль вагонов со свечой в руке и говорил своим подчиненным: «Япония побеждена. Мы возвращаем вас на родину. Но при всех условиях вы должны хранить тайну «отряда 731″. Если кто-то не сохранит ее, то я — Исии — найду такого человека где угодно и разделаюсь с ним. Поняли?»
Сытая жизнь в обмен на результаты
Но это была лишь угроза, хотя многие сотрудники отряда, исполняя последний приказ генерала, так и не раскрыв тайны «отряда 731», уже в мирное время умерли в нищете.
Сам же Исии, вернувшись в Токио, открыл гостиницу. Там его и нашли спецслужбы оккупационных войск. Американцы ликовали: Исии передал им ценнейшие материалы, которые можно использовать в дальнейшей работе над бакоружием. А советской стороне было отправлено заключение, что местопребывание руководства «отряда 731», в том числе и Исии, неизвестно и обвинять отряд в военных преступлениях нет оснований.
Так многие врачи-изуверы ушли от возмездия, прекрасно устроившись в мирной жизни. В обмен на результаты преступных исследований Исии и его подручных США не только сохранили им жизнь и уберегли от заслуженного наказания, но и позволили безбедно прожить все послевоенные годы.
По данным печати, в начале 80-х годов, когда Моримура писал свою книгу, около 450 бывших сотрудников «отряда 731» и других подобных формирований занимали видные посты в японской науке, медицине, промышленности. Среди них называли Р.Найто, президента фармацевтической компании «Грин-кросс», в которой впервые была создана искусственная кровь; одного из ведущих экспертов по проблеме выносливости человека в условиях холода X.Иосимуру; губернатора Токио С.Судзуки и других.
Вот такой на самом деле оказалась жуткая в своей жестокости и бесчеловечности история двух сохранившихся в Харбине зданий «отряда 731», так и не рассказанная мне симпатичной китаянкой-экскурсоводом.
От редакции
История «отряда 731» продолжается. Два года назад Высший суд Токио отверг иск десяти китайских граждан, требовавших, чтобы правительство Японии выплатило им 100 млн иен (почти миллион долларов) в качестве компенсации за страдания, причиненные во время японской агрессии в прошлом веке. Истцы назвали себя жертвами и родственниками жертв «отряда 731».
А сейчас Китай намерен обратиться в ЮНЕСКО с просьбой включить этот японский концлагерь под Харбином в список охраняемых исторических памятников. Однако официальная заявка будет подана после того, как площадь музея увеличат примерно в четыре раза. Реализация этого плана потребует около 60 миллионов долларов.
baik-info.ru
Отряд 731
Не людиОтряд был размещен в 1936 году около деревни Пинфан к юго-востоку от Харбина (на тот момент территория марионеточного государства Маньчжоу-го). Он располагался на территории шесть квадратных километров в почти 150 зданиях. Для всего окружающего мира это было Главное управление по водоснабжению и профилактике частей Квантунской армии. В «отряде 731» было все для автономного существования: две электростанции, артезианские скважины, аэродром, железнодорожная ветка. Была даже своя истребительная авиация, которая должна была сбивать все воздушные объекты (даже японские), которые без разрешения пролетали над территорией отряда. В отряд шли выпускники самых престижных японских университетов, цвет японской науки.
Отряд разместили в Китае, а не в Японии, по нескольким причинам. Во-первых, при дислокации его на территории метрополии очень сложно было соблюсти режим секретности. Во-вторых, в случае утечки материалов пострадало бы китайское население, а не японское. Наконец, в-третьих, в Китае всегда были под рукой «бревна». «Бревнами» офицеры и ученые подразделения называли тех, на ком испытывались смертоносные штаммы: китайских пленных, корейцев, американцев, австралийцев. Среди «бревен» было очень много наших соотечественников — белоэмигрантов, которые жили в Харбине. Когда запас «подопытных» в отряде подходил к концу, доктор Исии обращался к местным властям с просьбой о новой партии. Если под рукой у тех не было военнопленных, японские спецслужбы совершали рейды по ближайшим китайским населенным пунктам, пригоняя на «водоочистительную станцию» захваченных гражданских.
Первое, что делали с новичками, — откармливали. У «бревен» было трехразовое питание и даже иногда десерты с фруктами. Подопытный материал должен был быть абсолютно здоровым, дабы не нарушать чистоту эксперимента. Согласно инструкциям, любой сотрудник отряда, который посмел бы назвать «бревно» человеком, сурово наказывался.
«Мы считали, что “бревна” — не люди, что они даже ниже скотов. Впрочем, среди работавших в отряде ученых и исследователей не было никого, кто хоть сколько-нибудь сочувствовал “бревнам”. Все — и военнослужащие, и вольнонаемные отряда — считали, что истребление “бревен” — дело совершенно естественное», — говорил один из служащих.
«Они были для меня бревнами. Бревна нельзя рассматривать как людей. Бревна уже мертвые сами по себе. Теперь они умирали второй раз, и мы лишь исполняли смертный приговор», — говорил специалист по обучению персонала «отряда 731» Тошими Мизобучи.
В поисках чудо-оружия
Профильными экспериментами, которые ставились над подопытными, были испытания эффективности различных штаммов болезней. «Фавориткой» Исии была чума. Ближе к концу войны он вывел штамм чумной бактерии, в 60 раз превосходящий по вирулентности обычную. Эти бактерии хранились в сухом виде, а непосредственно перед использованием достаточно было лишь смочить их водой и небольшим количеством питательного раствора.
Эксперименты по выведению этих бактерий проводились над людьми. Например, в отряде были специальные клетки, куда запирали людей. Клетки были настолько маленькими, что пленники не могли пошевелиться. Их заражали какой-либо инфекцией, а затем днями наблюдали над изменениями состояния организма. Были и клетки побольше. Туда загоняли одновременно больных и здоровых, дабы отследить, насколько быстро болезнь передается от человека к человеку. Но каким бы образом его ни заражали, сколько бы ни наблюдали, конец был один — человека заживо препарировали, вытаскивая органы и наблюдая, как болезнь распространяется внутри. Людям сохраняли жизнь и не зашивали их целыми днями, дабы доктора могли наблюдать за процессом, не утруждая себя новым вскрытием. При этом никакой анестезии обычно не использовалось — врачи опасались, что она может нарушить естественный ход эксперимента.
Больше «повезло» тем, на ком испытывали не бактерии, а газы. Они умирали быстрее. «У всех подопытных, погибших от цианистого водорода, лица были багрово-красного цвета, — рассказывал один из служащих отряда. — У тех, кто умирал от иприта, все тело было обожжено так, что на труп невозможно было смотреть. Наши опыты показали, что выносливость человека приблизительно равна выносливости голубя. В условиях, в которых погибал голубь, погибал и подопытный человек».
Испытания биологического оружия проходили не только у Пинфаня. Помимо собственно основного здания «отряд 731» имел четыре филиала, расположенных вдоль советско-китайской границы, и один испытательный полигон-аэродром в Аньда. Туда возили заключенных, чтобы отрабатывать на них эффективность применения бактериологических бомб. Их привязывали к специальным шестам или крестам, вбитым по концентрическим кругам вокруг точки, куда затем сбрасывали начиненные чумными блохами керамические бомбы. Дабы подопытные случайно не умерли от осколков бомб, на них надевали железные каски и щиты. Иногда, впрочем, оставляли голыми ягодицы, когда вместо «блошиных авиабомб» использовались бомбы, начиненные специальной металлической шрапнелью с винтообразным выступами, на которые наносились бактерии. Сами ученые стояли на расстоянии трех километров и наблюдали за подопытными в бинокли. Затем людей везли назад на объект и там, как и всех подобных подопытных, вскрывали заживо, дабы пронаблюдать, как прошло заражение.
Впрочем, один раз такой эксперимент, проводившийся на 40 подопытных, завершился не так, как планировали японцы. Одному из китайцев удалось каким-то образом ослабить путы и спрыгнуть с креста. Он не убежал, а сразу же распутал ближайшего товарища. Затем они бросились освобождать остальных. Только после того, как все 40 человек были распутаны, все бросились врассыпную.
Японские экспериментаторы, увидевшие в бинокли, что происходит, были в панике. Если бы хотя бы один подопытный убежал, то сверхсекретная программа оказалась бы под угрозой. Не растерялся лишь один из охранников. Он сел в машину, помчался наперерез бежавшим и стал их давить. Полигон Аньда представлял собой огромное поле, где на протяжении 10 километров не было ни одного деревца. Поэтому большинство заключенных было раздавлено, а кое-кого даже удалось взять живыми.
Полевые испытания
После «лабораторных» испытаний в отряде и на полигоне научные сотрудники «отряда 731» проводили полевые испытания. С самолета над китайскими городами и селами сбрасывали начиненные чумными блохами керамические бомбы, выпускали чумных мух. В своей книге «Фабрика смерти» историк Калифорнийского государственного университета Шэлдон Хэррис утверждает, что от чумных бомб погибло более 200 тысяч человек.
Достижения отряда широко использовались и для борьбы с китайскими партизанами. Например, штаммами с брюшным тифом заражались колодцы и водоемы в местах, которые контролировали партизаны. Однако вскоре от этого отказались: часто под удар подпадали собственные войска.
Впрочем, японские военные уже убедились в эффективности работы «отряда 731» и стали разрабатывать планы применения бактериологического оружия против США и СССР. С боеприпасами проблем не было: по рассказам сотрудников, к концу войны в запасниках «отряда 731» накопилось столько бактерий, что если бы они при идеальных условиях были рассеяны по земному шару, этого оказалось бы достаточно, чтобы уничтожить все человечество. Но японскому истеблишменту не хватило политической воли — а может, хватило трезвости…
В июле 1944 года лишь позиция премьер-министра Тодзе спасла Соединенные Штаты от катастрофы. Японцы планировали с помощью воздушных шаров переправить на американскую территорию штаммы различных вирусов — от смертельных для человека до тех, которые будут губить скот и урожай. Тодзе понимал, что Япония уже явно проигрывает войну и при атаке биологическим оружием Америка может ответить тем же.
Несмотря на оппозицию Тодзе, японское командование в 1945 году до самого конца разрабатывало план операции «Вишня расцветает ночью». Согласно плану, несколько подлодок должно было подойти к американскому берегу и выпустить там самолеты, которые должны были распылить над Сан-Диего инфицированных чумой мух. По счастью, к тому моменту у Японии было максимум пять подлодок, каждая из которых могла нести по два-три специальных самолета. И руководство флота отказалось предоставить их для операции, мотивировав это тем, что все силы необходимо сконцентрировать на защите метрополии.
122 по Фаренгейту
Сотрудники «отряда 731» по сей день утверждают, что испытания биологического оружия на живых людях было оправданным. «Нет гарантии, что подобное никогда не повторится, — говорил с улыбкой в интервью New York Times один из участников этого отряда, встречавший свою старость в японской деревне. — Потому что в войне вам всегда надо побеждать».
Но дело в том, что самые страшные эксперименты, проводившиеся на людях в отряде Исии, не имели никакого отношения к биологическому оружию. Особо бесчеловечные опыты ставились в самых засекреченных помещениях отряда, куда даже не имела доступа большая часть обслуживающего персонала. Они имели исключительно медицинское предназначение. Японские ученые хотели знать пределы выносливости человеческого организма.
Например: солдаты императорской армии в Северном Китае зимой часто страдали от обморожения. «Опытным путем» доктора из «отряда 731» выяснили, что лучшим способом лечить обморожение было не растирание пострадавших конечностей, а погружение их в воду с температурой от 100 до 122 градусов по Фаренгейту. Чтобы это понять, «при температуре ниже минус 20 подопытных людей выводили ночью во двор, заставляли опускать оголенные руки или ноги в бочку с холодной водой, а потом ставили под искусственный ветер до тех пор, пока они не получали обморожение, — рассказывал бывший сотрудник отряда. — После небольшой палочкой стучали по рукам, пока они не издавали звук как при ударе о деревяшку». Затем обмороженные конечности клали в воду определенной температуры и, изменяя ее, наблюдали за отмиранием мышечной ткани на руках.
Среди таких подопытных был и трехдневный ребенок: дабы он не сжимал руку в кулачок и не нарушил чистоту эксперимента, ему воткнули в средний палец иголку.
Для императорских ВВС проводились эксперименты в барокамерах. «В вакуумную барокамеру поместили подопытного и стали постепенно откачивать воздух, — вспоминал один из стажеров отряда. — По мере того как разница между наружным давлением и давлением во внутренних органах увеличивалась, у него сначала вылезли глаза, потом лицо распухло до размеров большого мяча, кровеносные сосуды вздулись как змеи, а кишечник, как живой, стал выползать наружу. Наконец человек просто заживо взорвался». Так японские врачи определяли допустимый высотный потолок для своих летчиков.
Кроме того, для выяснения наиболее быстрого и эффективного способа лечить боевые ранения людей взрывали гранатами, расстреливали, сжигали из огнеметов…
Были и эксперименты просто для любопытства. У подопытных вырезали из живого тела отдельные органы; отрезали руки и ноги и пришивали назад, меняя местами правые и левые конечности; вливали в человеческое тело кровь лошадей или обезьян; ставили под мощнейшее рентгеновское излучение; оставляли без еды или без воды; ошпаривали различные части тела кипятком; тестировали на чувствительность к электротоку. Любопытные ученые заполняли легкие человека большим количеством дыма или газа, вводили в желудок живого человека гниющие куски ткани.
Впрочем, из подобных «бесполезных» экспериментов получался и практический результат. Например, так появилось заключение о том, что человек на 78% состоит из воды. Чтобы это понять, ученые сначала взвесили пленника, а затем поместили его в жарко натопленную комнату с минимальной влажностью. Человек обильно потел, но ему не давали воды. В итоге он полностью высыхал. Затем тело взвешивали, при этом оказывалось, что весит оно около 22% от первоначальной массы.
Набить руку
Наконец, японские хирурги просто набивали руку, тренируясь на «бревнах». Один из примеров подобной «тренировки» описывается в книге «Кухня дьявола», написанной самым известным исследователем «отряда 731» Сэйити Моримурой.
Цитата: «В 1943 году в секционную привели китайского мальчика. По словам сотрудников, он не был из числа “бревен”, его просто где-то похитили и привезли в отряд, но точно ничего известно не было. Мальчик разделся, как ему было приказано, и лег на стол спиной. Тотчас же на лицо ему наложили маску с хлороформом. Когда наркоз окончательно подействовал, все тело мальчика протерли спиртом. Один из опытных сотрудников группы Танабэ, стоявших вокруг стола, взял скальпель и приблизился к мальчику. Он вонзил скальпель в грудную клетку и сделал разрез в форме латинской буквы Y. Обнажилась белая жировая прослойка. В том месте, куда немедленно были наложены зажимы Кохера, вскипали пузырьки крови. Вскрытие заживо началось. Из тела мальчика сотрудники ловкими натренированными руками один за другим вынимали внутренние органы: желудок, печень, почки, поджелудочную железу, кишечник. Их разбирали и бросали в стоявшие здесь же ведра, а из ведер тотчас же перекладывали в наполненные формалином стеклянные сосуды, которые закрывались крышками. Вынутые органы в формалиновом растворе еще продолжали сокращаться. После того как были вынуты внутренние органы, нетронутой осталась только голова мальчика. Маленькая, коротко остриженная голова. Один из сотрудников группы Минато закрепил ее на операционном столе. Затем скальпелем сделал разрез от уха к носу. Когда кожа с головы была снята, в ход пошла пила. В черепе было сделано треугольное отверстие, обнажился мозг. Сотрудник отряда взял его рукой и быстрым движением опустил в сосуд с формалином. На операционном столе осталось нечто, напоминавшее тело мальчика, — опустошенный корпус и конечности».
В этом «отряде» не было никаких «отходов производства». После экспериментов с обморожением покалеченные люди шли на опыты в газовые камеры, а органы после экспериментальных вскрытий поступали в распоряжение микробиологов. Каждое утро на специальном стенде висел перечень того, в какой отдел пойдут какие органы от намеченных к вскрытию «бревен».
Все опыты тщательно документировались. Помимо кипы бумаг и протоколов в отряде было около 20 кино— и фотокамер. «Десятки и сотни раз мы вдалбливали себе в голову, что подопытные не люди, а всего лишь материал, и все равно при вскрытиях заживо у меня мутилось в голове, — рассказывал один из операторов. — Нервы нормального человека этого не выдерживали».
Некоторые опыты фиксировал на бумаге художник. В то время существовала лишь черно-белая съемка, и она не могла отразить, например, изменение цвета ткани при обморожении…
Оказались востребованы
По воспоминаниям сотрудников «отряда 731», всего за время его существования в стенах лабораторий погибло около трех тысяч человек. Но некоторые исследователи утверждают, что реальных жертв было гораздо больше.
Конец существованию «отряда 731» положил Советский Союз. 9 августа советские войска начали наступление против японской армии, и «отряду» было приказано «действовать по собственному усмотрению». Работы по эвакуации начались в ночь с 10 на 11 августа. Важнейшие материалы — описания применения бактериологического оружия на территории Китая, кипы протоколов вскрытий, описания этиологии и патогенеза, описания процесса культивирования бактерий — сжигали в специально вырытых ямах.
Было решено уничтожить и остававшиеся на тот момент в живых «бревна». Часть людей отравили газом, а некоторым было благородно позволено покончить жизнь самоубийством. Трупы сбросили в яму и сожгли. Первый раз сотрудники отряда «схалтурили» — трупы сгорели не до конца, и их просто забросали землей. Прознав об этом, начальство, несмотря на спешку эвакуации, приказало трупы выкопать и сделать работу «как надо». После второй попытки пепел и кости были сброшены в реку Сунгари.
Туда же были выброшены и экспонаты «выставочной комнаты» — огромного зала, где в наполненных специальным раствором колбах хранились отрезанные человеческие органы, конечности, разрубленные разным способом головы, препарированные тела. Часть из этих экспонатов были зараженными и демонстрировали различные этапы поражения органов и частей тела человека. Выставочная комната могла бы стать самым наглядным доказательством бесчеловечной сущности «отряда 731». «Недопустимо, чтобы в руки наступающих советских войск попал хотя бы один из этих препаратов», — заявило руководство отряда подчиненным.
Но часть наиболее важных материалов была сохранена. Их вывезли Сиро Исии и некоторые другие руководители отряда, передав все это американцам — как своего рода выкуп за свою свободу. Для США эта информация имела чрезвычайную важность.
Американцы начали свою программу развития биологического оружия лишь в 1943 году, и результаты «полевых опытов» их японских визави оказались как нельзя кстати.
«В настоящее время группа Исии, тесно сотрудничая с США, готовит большое количество материалов для нас и дала согласие предоставить в наше распоряжение восемь тысяч слайдов, на которых запечатлены животные и люди, подвергшиеся бактериологическим экспериментам, — говорилось в специальном меморандуме, распространенном среди избранных лиц госдепартамента и Пентагона. — Это крайне важно для безопасности нашего государства, и ценность этого значительно выше того, чего мы достигли бы, возбудив судебное расследование военных преступлений… В связи с чрезвычайной важностью информации о бактериологическом оружии японской армии правительство США решает не обвинять в военных преступлениях ни одного сотрудника отряда по подготовке бактериологической войны японской армии».
Поэтому в ответ на запрос советской стороны о выдаче и наказанию членов отряда в Москву было передано заключение о том, что «местопребывание руководства “отряда 731”, в том числе Исии, неизвестно и обвинять отряд в военных преступлениях нет оснований».
В целом в «отряде 731» работало почти три тысячи ученых (включая тех, кто трудился на вспомогательных объектах). И все они кроме тех, кто попал в руки СССР, избежали ответственности. Многие из ученых, препарировавших живых людей, стали в послевоенной Японии деканами университетов, медучилищ, академиками, бизнесменами. Среди них были губернатор Токио, президент японской медицинской ассоциации, высокопоставленные сотрудники Национального института здравоохранения. Военные и врачи, которые работали с «бревнами»-женщинами (в основном экспериментировали с венерическими заболеваниями), после войны открыли частный родильный дом в районе Токай.
Принц Такеда (двоюродный брат императора Хирохито), который инспектировал «отряд», тоже не понес наказания и даже возглавил японский Олимпийский комитет в преддверии Игр 1964 года. А сам злой гений отряда — Сиро Исии — безбедно жил в Японии и умер от рака в 1959 году.
Слабонервным людям с хрупкой психикой настоятельно не рекомендуеться смотреть фильм «Философия ножа»!!!
bugaga.ru
Японский отряд 731 (впечатлительным не смотреть)
Главная » история » Японский отряд 731 (впечатлительным не смотреть)

Отряд 731 (википедия)














Понравилась публикация? Поделись ссылкой с друзьями!
Опубликовано 19.11.2014 в рубрике: история.Ранее в этой же рубрике:
www.daokedao.ru
